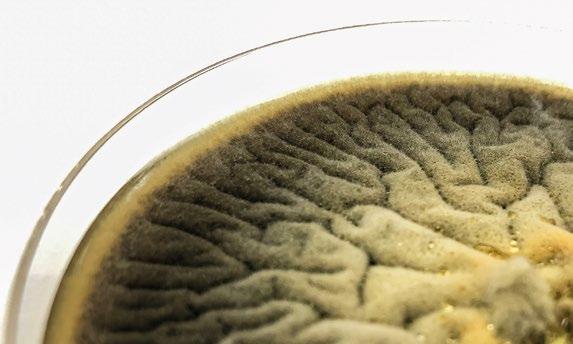

Depresión, velocidad del aire y la trayectoria del aire entrante 06


Michael Czarick1 , Brian Fairchild2
1UGA Extension Engineer
2UGA Extension Poultry
Scientist
Traducción: Serafín García Freire
Aturdido y calidad de la canal del pollo de engorde 14

Manuel Sanz
Ingeniero Agrónomo - PhD
Control de proceso: 30 aspectos puntuales a evaluarse durante la prefaena hasta el sacrificio 24

Eduardo Cervantes López
Consultoría Internacional - Gerencia Productiva e Innovadora en Procesamiento de Aves, Barranquilla, Colombia.
Puntos clave de manejo de las reproductoras en las 32


Sara Llorens Equipo Técnico Aviagen
De Abuelos a Nietos: 50 Años de avicultura familiar con Comavic 42



Importancia del tamaño del huevo 56
Equipo Técnico H&N
Costos de producción en avicultura de puesta 64

74
Joan Monllao
Director de Operaciones de Ous Roig Tortosa, SAU; Hevo Group
84
El manejo de los lotes de aves que tienen el pico completo. Parte 1
Equipo Técnico Hy Line
Soluciones a medida con Cosma y sus cobertizos multifuncionales




Alfredo Corujo Dtor Masterlab1 y Rosa Franco-Rosselló2
1Nutreco Animal Nutrition Iberia
2Poultry Resercher, Trouw Nutrition R&D Poultry Research Centre




Propiedades desinfectantes aún más poderosas
El único biocida con registro EU-BPR en clasificación PT02, PT03, PT04 y PT05
Más sostenible y preparado para los retos del futuro
PT02, PT03, PT04, PT05
MEZCLA ÚNICA
MÁS FUERTE A TRAVÉS DE INNOVACIÓN


*Intra Hydrocare tiene su propio registro EU-BPR para uso en ganadería. Con una clasificación PT05, Intra Hydrocare es el único biocida basado en peróxido de hidrógeno permitido para uso en agua potable hasta un dosis de 250 ml por 1.000 litros de agua mientras los animales están presentes. Esto hace Hydrocare único!
Pioneros en soluciones preparadas para el futuro

QUIERE SABER MÁS?



Todos los días nos encontramos en los medios de comunicación con declaraciones y noticias que unos u otros las califican como “NOTICIAS FALSAS o FAKE NEWS”.
Desgraciadamente este asunto en el mundo alimentario debería ser un tema mucho más controlado. Hay empresas que intentan aprovecharse y sacar un beneficio comercial con un etiquetado incorrecto debido a veces a puntos no bien definidos en algunas legislaciones o directamente con intenciones de engaño comercial.
Urge tomar medidas para evitar que se confunda y engañe al consumidor. Ni la bebida de soja o de avena es leche, ni hay hamburguesas de pollo de guisantes, ni existe merluza de soja.
Parece evidente que es necesario y urgente tomar medidas para evitar que se siga confundiendo al consumidor. Las administraciones autonómicas tienen que ser mucho más exigentes con este tema y utilizar incluso los cauces judiciales para poner orden en aquellos casos que haya empresas que quieran aprovecharse de estas situaciones.
Han pasado siete años desde que el Tribunal de Justicia de la UE sentenciara que las etiquetas de mantequilla de tofu, la leche de avena o el queso vegetal no son válidas. Estableciendo de forma clara que los productos vegetales no podían comercializarse con esas denominaciones, puesto que son conceptos reservados por derecho comunitario a los productos de origen animal.
Hace un año en España se activó el debate en las empresas de alimentación, como consecuencia de la nueva proliferación de imitaciones, que en realidad eran derivados de proteínas vegetales ultra procesadas y de falsos mensajes para confundir a los consumidores. Empresas o marcas como HEURA, SEE SO GOOD o LA SIRENA ya han sido denunciadas por seguir estas prácticas.
Administraciones, organizaciones de consumidores ( OCU ) y organizaciones de productores ya han empezado a denunciar estas acciones y deberían de seguir también este camino otras organizaciones y empresas del sector.
El NOMBRE de las empresas y las MARCAS que actúan de esta forma deberían de ser llevadas a conocimiento de la mayor cantidad de consumidores que se pueda y de esta forma dar a conocer la estrategia que quieren algunos de aprovecharse de la confusión en los consumidores.
Para poner freno al problema no es necesario elaborar ninguna normativa nueva porque la legislación está ya clara al respecto. La comercialización de estos productos incumple dos normativas en el ámbito de la competencia: la Directiva europea de 2005 relativa a las prácticas comerciales desleales asegurando que son aquellas actuaciones engañosas “que contengan información falsa o información que, aun siendo veraz, por su contenido o presentación induzca o pueda inducir a error a los destinatarios” y la Ley de Seguridad Alimentaria y Nutrición, que establece que “el etiquetado y las modalidades de realizarlo no deberán ser de tal naturaleza que induzcan a error al comprador, especialmente sobre las características del producto”.
EDITOR
GRUPO DE COMUNICACIÓN AGRINEWS S.L.
PUBLICIDAD
Luis Carrasco
+34 605 09 05 13 lc@agrinews.es
Félix Muñoz
+34 618 18 00 16 felix@mediatarsis.com
DIRECCIÓN TÉCNICA
José Luis Valls
REDACCIÓN
Osmayra Cabrera
Gerard Ponz
F.X. Mora
Daniela Morales
COLABORADORES
Juan Carlos Abad
José Ignacio Barragán
Luis Canela
Serafín García Freire
Edgar Oviedo Rondón
Juan Carlos López
Mike Czarick
Santiago Vega
Eduardo Cervantes
Gonzalo González Mateos
Barcelona - España
Tel: +34 93 115 44 15 info@agrinews.es avinews.com
Precio de suscripción anual: España 36 €
Extranjero 125 €
DIRIGIDA A VETERINARIOS Y TÉCNICOS
Depósito Legal aviNews B11597-2013
ISSN (Revista impresa) 2696-8061
ISSN (Revista digital) 2696-807X
Revista bimestral
La dirección de la revista no se hace responsable de las opiniones de los autores. Todos los derechos reservados. Imágenes: Noun Project / Freepik/Dreamstime
Michael Czarick 1 & Brian Fairchild 2
1UGA Extension Engineer
2UGA Extension Poultry Scientist
Traducción: Serafín García Freire

La ventilación con presión negativa es el método más popular para ventilar granjas avícolas en épocas frías debido a su simplicidad y a los costos iniciales relativamente bajos.


Los extractores crean presión negativa dentro de la nave y le dan al avicultor un control preciso sobre la cantidad de aire fresco que entra en la nave.
Las entradas de aire distribuyen el aire frío exterior, aspirado por los extractores, uniformemente por toda la nave y lo dirigen a lo largo del techo, donde el aire caliente (producido por las aves y el sistema de calefacción) se acumula cerca del techo; de forma que el aire fresco se calentará antes de bajar al nivel de las aves.
Una de las características más importantes de la ventilación por presión negativa es que le da al avicultor el control sobre la velocidad a la que el aire limpio y frío exterior entra en la nave.

No importa si la nave mide 30 o 200 metros de largo; No importa si la nave tiene 9 o 18 metros de ancho; No importa si la nave tiene pollos de carne, ponedoras, reproductoras o patos.
Con unas entradas de aire adecuadas y el nivel adecuado de presión negativa, es relativamente sencillo proporcionar aire fresco y cálido a todas las aves de una nave con un mínimo coste y esfuerzo.
El objetivo durante el clima frío es maximizar la distancia que recorre el aire fresco entrante a lo largo del techo antes de bajar al nivel de las aves.
Cuanto más rápido entre el aire en la nave, más tiempo permanecerá cerca del techo, más se mezclará con el aire caliente que se acumula cerca del techo y es menos probable que enfríe a las aves cuando descienda al suelo
Además, a medida que aumenta la temperatura del aire entrante, aumenta su capacidad para retener la humedad, lo que lo hace más eficaz para eliminar la humedad de la cama.
Si el aire frío y pesado que entra por las trampillas de una nave no entra con suficiente velocidad, tenderá a caer rápidamente al suelo al entrar en la nave, lo que provocará que los pollitos se enfríen y la cama se apelmace.










PANELES PLASTICOS Y DE CELULOSA
ESPESORES: 10cm y 15 cm
ALTURAS: 100cm, 150cm, 180cm y 200cm
PANELES PLASTICOS Y DE CELULOSA
ESPESORES: 10cm y 15 cm
ALTURAS: 100cm, 150cm, 180cm y 200cm






GRAN VARIEDAD EN CUADROS DE REFRIGERACIÓN PARA TRABAJAR POR DEPRESIÓN O POR SOBREPRESIÓN

GRAN VARIEDAD EN CUADROS DE REFRIGERACIÓN PARA TRABAJAR POR DEPRESIÓN O POR SOBREPRESIÓN

INFORMACIÓN:

En ventilaciones por presión negativa, la depresión determina la velocidad de entrada de aire a través de las entradas de aire de la nave.
Cuanto mayor sea la depresión, más rápido entrará el aire en la nave.
Cuanto menor sea la depresión, más lentamente entrará el aire en la nave.

La relación entre la depresión y la velocidad de entrada de aire está muy bien definida.
De hecho, se puede conocer la depresión de la nave midiendo la velocidad del aire que entra en la nave a través de una trampilla de la pared lateral y usando el Gráfico 1.

Gráfico 1. Relación entre la velocidad de entrada del aire y la depresión.
A menudo se piensa que el factor principal que determina la depresión óptima para una nave es el ancho de la nave.
Es lógico que cuanto más ancha sea la nave, mayor será la velocidad del aire requerida para que el aire entrante llegue al centro de la nave y, por lo tanto, mayor será la depresión requerida.
Pero, en realidad, el factor principal que determina la depresión óptima es el frío que hace afuera, o más concretamente, la diferencia de temperatura del aire entre el interior y el exterior de la nave.
Esto tiene sentido si consideramos por qué utilizamos entradas de aire... para mantener el aire frío y pesado cerca del techo, y que se caliente antes de bajar al suelo.

Si el aire entrante es cálido y relativamente ligero, ¿por qué se va a caer al suelo?
Después de todo, si tiene casi la misma temperatura que el aire caliente de la nave, no es más pesado que el aire de la nave y, por tanto, tenderá a permanecer cerca del techo.
Ahora bien, si el aire entrante es mucho más frío y por tanto más pesado que el aire de la nave, tenderá a caer al suelo rápidamente, en el caso que entre en la nave a baja velocidad.*
Se han desarrollado ecuaciones para predecir el alcance del aire a lo largo del techo que entra a través de una trampilla antes de bajar al nivel del suelo, en función de varios factores (como por ejemplo, presión estática, tamaño de la abertura de entrada, tipo de entrada, posición de la entrada, etc.).

Aunque no proporcionan respuestas precisas para cada situación, estas ecuaciones se pueden utilizar para explorar cómo factores como las diferencias de temperatura interior/exterior afectan a la trayectoria del aire entrante.
Por ejemplo, para una trampilla de estilo europeo típica colocada cerca de un techo liso, abierta 5 centímetros, a una presión estática de 27 pascales, la lámina de aire viajará aproximadamente 8 metros a lo largo del techo antes de bajar al nivel del suelo cuando la temperatura exterior sea de 21 oC y 27 oC en el interior (ver Tabla 1).
Pero si la temperatura exterior cae a -1 oC, ¡la distancia recorrida se reducirá a solo 3,3 metros!
Depresión (Pascales)
Tabla 1. Distancia teórica (en metros) que viajará el aire desde una trampilla europea, ubicada en la parte superior de la pared lateral, a lo largo de un techo liso cuando se abre 5 centímetros con una temperatura de la nave de 27 ºC (de la ecuación desarrollada por el Dr. Steven Hoff, Universidad Estatal de Iowa ).
*Nota del traductor: Sólo algunos modelos de ordenadores avícolas disponibles en el mercado español tienen la función de aumentar progresivamente la depresión de la nave (en algunos ordenadores) o la velocidad de entrada de aire (en otros ordenadores) a medida que baja la temperatura exterior. Esta función es altamente recomendable para conseguir una trayectoria de aire entrante adecuada cuando la temperatura exterior es baja; y cuando la temperatura exterior aumenta, el ordenador progresivamente va reduciendo la depresión/velocidad de entrada de aire, aumentando la eficiencia de los extractores (metros cúbicos de aire por hora y por vatio consumido).


Por lo tanto, durante una tarde de otoño, el aire que entra por una trampilla podría fácilmente llegar al centro de una nave de 15 metros de ancho, pero por la noche, el aire entrante frío podría caer al suelo a poco más de 3 metros de distancia de la pared lateral.
El ambiente para las aves podría ser excelente por la tarde y relativamente frío por la noche con la misma abertura de entrada, depresión y mismos extractores funcionando.

Aunque generalmente se requieren velocidades de entrada de aire más altas a medida que bajan las temperaturas exteriores, es importante tener en cuenta de que programando mayores valores de depresión en el ordenador, puede no mejorar la trayectoria del aire entrante.
Por eso es tan importante que los avicultores evalúen la trayectoria del aire entrante cuando las temperaturas exteriores son las más bajas.
Si el alcance del aire entrante es aceptable a primera hora de la mañana o en la noche, es probable que la trayectoria del aire entrante siga siendo aceptable a medida que las temperaturas exteriores aumenten durante el día.

Esto se debe a que el ordenador de una nave aumenta la depresión disminuyendo el tamaño de la abertura de entrada.
Como se puede suponer, a medida que disminuye el tamaño de la abertura de entrada, disminuye el flujo de aire de las trampillas.

Es por eso por lo que, a veces, es mejor aumentar la depresión cerrando una parte de las trampillas de la nave (es decir, 1/4, 1/3, etc.).
Esto permitirá al avicultor aumentar la depresión sin reducir el tamaño de apertura de las trampillas.



Aunque no existe una depresión única que funcione en todos los casos, generalmente se recomienda usar una depresión entre 12 y 32 pascales (4,6 y 7,1 metros/segundo) en la mayoría de las naves.
Programar depresiones más bajas funcionan mejor durante climas moderados a cálidos con aberturas de entrada más grandes (5 centímetros o más).
Por el contrario, depresiones más altas son más adecuadas para climas más fríos con aberturas de entrada más pequeñas (de 3 a 5 centímetros).
Determinar la depresión óptima y la apertura de entrada requerirá experimentar pruebas de ensayo y error.
Los avicultores pueden ver la trayectoria del flujo de aire entrante fijando al techo un trozo de cinta de inspección de 13 a 25 centímetros frente a una o dos trampillas cada pocos metros desde la pared lateral hasta el punto más alto del techo.
Cuando los extractores de ventilación mínima están funcionando, la cinta de inspección más cercana a la pared lateral debe posicionarse paralela al techo, mientras que la más cercana al punto más alto del techo apenas debe moverse, lo que indica que el aire se está moviendo lentamente hacia el suelo.
Dado que el circuito del aire variará con la temperatura exterior, los avicultores deben realizar observaciones a lo largo del día, prestando especial atención por la mañana temprano y en la noche, cuando las temperaturas exteriores son más bajas. Los avicultores a menudo encontrarán que, si consiguen que el aire entrante llegue cerca del centro de la nave durante las horas más frías del día, la trayectoria del aire irá mejorando a medida que las temperaturas exteriores aumenten a lo largo del día.
Depresión, velocidad del aire y la trayectoria del aire entrante DESCÁRGALO EN PDF
Manuel Sanz
Consultor y Auditor internacional
Calidad
y Bienestar Animal

El término de calidad es un término amplio y difícil de definir, pero se podría convenir que esto es todo aquello por lo que el consumidor está dispuesto a pagar.
Sin embargo, en el ámbito de este trabajo podríamos simplificar esta definición diciendo que la CALIDAD es la ausencia de todos aquellos defectos en la canal o en la carne que provocan un rechazo por parte del consumidor.
Concretando aún más, diríamos que una canal (carne) de calidad es la que está libre de “rojeces”, hematomas, desgarros o defectos en la piel, plumas, etc.
Es bien conocido que existen multitud de factores que pueden afectar a la aparición de estos defectos o lesiones en las canales de pollo.
Entre otras, estos factores se pueden clasificar entre aquellos que afectarán a la calidad antes del proceso de sacrifico (Factores Pre-sacrificio) y los que tienen lugar durante el procesado de las aves en la planta de sacrificio (Factores Sacrificio)
Aspectos como la densidad de aves en la granja, el manejo en la explotación, el tipo y la cantidad de la cama, el manejo de agua de bebida, las prácticas durante la carga, el transporte, la espera y la descarga, etc.pueden influir de forma importante en la aparición de defectos en la canal si no se realizan correctamente.
Del mismo modo los procesos sucesivos en la planta de procesamiento desde el aturdido, pasando por el corte, sangrado, escaldado, desplumado, eviscerado, etc. pueden provocar también la aparición de defectos en el producto final.



FACTORES PRE-SACRIFICIO
Densidad Granja
Tipo de Cama
Carga + Transporte

FACTORES SACRIFICIO

Aturdido
Sangrado
Escaldado
Desplumado
Sin embargo, en el presente trabajo nos centraremos en los efectos que sobre la calidad de la canal y de la carne puede tener solo uno de los factores mencionados, el aturdido, y atenderemos a dos de los sistemas de aturdido más comúnmente empleados en la industria: Aturdido Eléctrico en Baño de Agua y Aturdido por Gas.
El sistema de aturdido eléctrico en baño de agua es uno de los sistemas que históricamente ha sido más utilizado en las plantas procesadoras de pollos de engorde.
Simplificando, desde un punto de vista eléctrico, un aturdidor en baño funciona como un circuito de resistencias en paralelo en el que las aves actúan como resistencias.
Tanto desde el punto de vista de la eficacia del aturdido, como desde el punto de vista de la calidad, hay dos parámetros eléctricos importantes que son la intensidad de corriente (I = amperios) y la frecuencia de la corriente (Hz = Hercios).
Desde luego existen otros parámetros eléctricos que también pueden tener efectos en la efectividad como por ejemplo si se trata de corriente alterna (AC) o corriente continua (DC) directa o pulsada etc..(Raj 2009) aunque sus efectos no serán objeto de este trabajo.

ATURDIDO ELÉCTRICO EN BAÑO DE AGUA
Intensidad corriente (I)= mA
Frecuencia = Hz

En general, es comúnmente aceptado que a mayor intensidad de corriente mayores serán los problemas de calidad asociados con el aturdidor provocando lesiones de hemorragias en pechugas y cara interna de muslos, horquillas rotas, y puntas de las alas rotas (Sirry et al., 2017, Abdalla et al., 2007).
Intensidad
Calidad
Efecto de la intensidad (mA) en defectos de canal

Puntas de ala rojas % Hemorragias pechuga % Milamperios*
Huesos rotos%
Gráfico 1. Abdalla et al., 2007. * Adaptado asumiendo una resistencia de las aves de 1000 ohmios.

Efecto de la intensidad (400 mA) en lesiones de
Gráfico 2. Sirri et al., 2017
Por otro lado, también se acepta que cuanto más alta sea la frecuencia de la corriente aplicada menores serán los problemas de calidad (Wilkins et al 1999)
FRECUENCIA + Intensidad + Frecuencia - Calidad +Calidad
Es por tanto lógico inferir que los aturdidores deben ser ajustados para aplicar una corriente con la menor intensidad y la mayor frecuencia posible.



Sin embargo, no se debe olvidar que en la UE estos parámetros eléctricos de aturdido están regulados por la normativa vigente (Reglamento 1099/2009) (Tabla1).
(H z)
(m
de la frecuencia (120 mA) en las
3. Wilkins et al., 1999
Tabla 1. Requisitos eléctricos para pollo del equipamiento de aturdimiento por baño de agua establecidos en el Reglamento 1099/2009
Por tanto, teniendo en cuenta estos requisitos, la recomendación sería irse a los valores más altos de frecuencias autorizados para una determinada intensidad. P.Ej.- 190Hz para 100mA/ave o 390 Hz para 150mA/ave
Finalmente es importante recordar que el funcionamiento del sistema de aturdido en baño de agua implica necesariamente algunos problemas inevitables, como:
la necesidad de colgar las aves aún vivas en la línea de sacrificio. El hecho de que la intensidad de corriente (mA) que se aplica a cada ave no va a ser idéntico en todas ellas,
puesto que depende de la resistencia de cada una de ellas (Bilgili, 1992)(Ley de Ohm) o que si el baño no está bien diseñado se puedan producir choques eléctricos pre-aturdido.
Todos ellos, además de tener efectos no deseables sobre el bienestar de las aves y la eficacia del aturdido, podrían afectar también la calidad de la canal provocando aleteos y movimientos indeseables antes y durante el aturdido.

Otro sistema de aturdido ampliamente utilizado es el aturdido por gas.
Con este sistema se provoca primero el estado de inconsciencia del ave y luego su muerte cerebral por anoxia
En general, cuando se modifica la atmósfera, las aves muestran una serie de síntomas que se inician con señales de alerta, como la apertura del pico, seguida de los signos de dificultad para respirar (jadeos).
Finalmente, las aves suelen perder el equilibrio o su postura normal acompañado de la aparición de aleteos intensos, saltos y espasmos o convulsiones musculares.

Al final del proceso los animales mostrarán una pérdida total de movimiento (McKeegan et al., 2007b, Abeyesinghe et al., 2007).
Son precisamente estos aleteos y convulsiones los que parecen responsables de que el aturdido por gas también pueda tener efectos negativos sobre la calidad de la canal y de la carne por lo que es recomendable emplear mezclas de gases que los minimicen (con presencia de O2 y de la forma mas gradual posible) (MacKeegan et al., 2007; Gerriztzen et al. (2013)

ATURDIDO GAS
Ar vs C02+O2
Efecto de diferentes gases en los espasmos musculares

Los mismos autores en un trabajo posterior mostraron que la incidencia de alas rotas, horquillas rotas y hemorragias en pechuga era inferior en aves aturdidos con un gas sin O2 (Ar+CO2) que con un sistema en dos fases en presencia de O2 (1ªFASE 40/30/302ªFASE 80/5/15 CO2 /O2 /N2.) lo que ilustró la relación directa entre aleteos y convulsiones y calidad de la canal.
Gráfico 4. McKeegan et al., 2007
Efectivamente, en un interesante trabajo MacKeegan et al (2007), mostraron que la duración de los aleteos y espasmos musculares era significativamente superior en aves aturdidas empleando un gas sin presencia de O₂ (Argón) que cuando se empleaba un sistema en dos fases con mezclas de CO2 y O2 ó aire (40% CO2 + 30% O2 en N2 seguido de 80% CO2 en aire)
Gerriztzen et al. (2013) mostraron también que la cantidad e intensidad de las convulsiones fue superior en pollos aturdidos con un sistema de C02 en aire con 4 fases (desde 20 hasta 65% en 4 minutos) que en un sistema con 5 fases (desde 18 hasta 62% en 6 minutos)

Gráfico 4. McKeegan et al., 2007
Parece generalmente aceptado que el aturdido por gas disminuye significativamente los problemas de calidad asociados al aturdido en baño de agua eléctrica, es decir, hematomas en pechugas, clavículas rotas, hemorragias internas en muslos etc.. (Raj et al., 1990; Kang & Sams, 1999).
Gas > Eléctrico
Efecto del método de aturdido Gas (45% CO2 en aire) vs Elect. (105 mA 50Hz) en las lesiones de la canal (%)
70
pechuga
Gráfico 5. Raj et al., 1990
Efecto del método de aturdido (CO2 en 5 fases 20-85% + O2 21% inicio) vs Elect. (20mA ?? H<) y daños en alas (%)
4,0
Gráfico 6. Riggs et al., 2023
Sin embargo, como hemos visto esto dependerá de los parámetros eléctricos empleados en el baño y del tipo de gas utilizado en el aturdido por gas.
Por ejemplo, en un trabajo reciente Riggs et al. (2023) mostraron que el porcentaje de canales con alas dañadas en pollos aturdidos en baño de agua eléctrico era significativamente inferior (2,2%) que en pollos aturdidos con gas (3,6%).
Estos resultados parecerían contradecir la afirmación de que el aturdido con gas mejora la calidad de la canal, pero se debe tener en cuenta que:
el sistema de aturdido eléctrico empleado en el ensayo aplicaba una corriente de solo 20mA por ave
mientras que el aturdido por gas se realizó usando un sistema en 5 fases de CO2 (desde el 20% al 85% durante 5 minutos) en mezcla con O2 (un 21% los primeros 90 seg), es decir, un sistema que minimiza

0,4
Efecto del método de aturdido (CO2+ O2)* vs Elect. (125 V 50Hz)** en desplumado
Gráfico 7. Abeyesinghe et al., 2007
Por otro lado las empresas que cambian desde un sistema de aturdido en baño de agua hacia un sistema de aturdido por gas suelen reportan una mayor dificultad en el desplumado de las aves.
Efectivamente, Abeyesinghe et al. (2007) observaron que el porcentaje de canales con 2 o mas plumas en pollos aturdidos en baño de agua eléctrico (125 V 50Hz 5 seg) fue significativamente inferior al de pollos aturdidos con gas (Ar ó Ar+CO2 ó CO2+O2) (0,20 vs 0,47%), resultados que refuerzan la hipótesis de que desplumar las aves aturdidas por gas es más complicado.
*fase 1 -- CO2 40% + O2 30% (75 seg); fase 2 -- CO2 80% (75-185 seg)
*125 V = 150 mA/ave asumiendo resistencia de 1000 Ohms (5 seg)
Aunque, hasta lo que el autor conoce, las razones por las que el desplumado en los sistemas de aturdido por gas es más complejo, son desconocidas, podrían estar relacionadas sencillamente con el hecho de que los tiempos que transcurren desde el aturdido hasta la etapa de escaldado y posterior desplumado son muy superiores en el caso del aturdido por gas en comparación con el aturdido en baño de agua eléctrico.

Aunque no tan extendidos a nivel europeo como los dos anteriores, existen disponibles comercialmente otros dos sistemas de aturdido autorizados por la EFSA:
Aturdimiento eléctrico limitado a la cabeza
Aturdimiento por baja presión atmosférica
El sistema consiste en la instalación en la línea de sacrificio de un mecanismo que permite “pinzar” una a una las cabezas de las aves y aplicar una corriente eléctrica.
Aunque no hay mucha literatura científica al respecto, este sistema podría arrojar algunas ventajas frente al baño de agua puesto que es capaz de aplicar exactamente la misma cantidad de corriente a cada ave (min 240mA/ave), que además puede ser registrada individualmente.

Además como la corriente se aplica sólo a la cabeza, podría evitar las hemorragias (Lambooij et al 2014) en pechugas debidas a las fuertes contracciones musculares que el paso de la corriente por todo el cuerpo provoca.
En cuanto a sus inconvenientes parece que podría causar más problemas en alas debido a que provoca fuertes aleteos, la duración de la inconsciencia es muy corta por lo que es necesario realizar el corte y sangrado lo antes posible.
En este caso las aves se introducen en un sistema de descompresión que va reduciendo gradualmente los niveles de O2 hasta alcanzar valores al menos inferiores al 5%.
De acuerdo a algunos autores (Thaxton, 2018
Martin el at., 2016) los síntomas de las aves aturdidas con este sistema serian similares a los síntomas de aves aturdidas con gases inertes, y causadas básicamente por los efectos de la hipoxia, y en teoría, peores en términos de calidad de canal que los de un aturdido con gas empleando mezclas de CO2 y O2 o aire en varias fases.
¿Cómo definir correctamente los parámetros de incubación modernos?
DESCÁRGALO EN PDF


ATURDIDO ELÉCTRICO SÓLO CABEZA
Además, debido a que el sistema se instala en línea algunas aves podrían “escapar” al “pinzado” por lo que se hace necesario disponer de un sistema de respaldo que garantice el aturdido del 100% de las aves.
Eduardo Cervantes López
Consultoría Internacional - Gerencia Productiva e Innovadora en Procesamiento de Aves, Barranquilla, Colombia.

El control de proceso centra la atención en los detalles y/o microdetalles que afectan la calidad y el rendimiento de los pollos que se faenan diariamente. El control de proceso es un concepto gerencial utilizado por Toyota.
El propósito de este artículo es relacionar los aspectos más importantes en cada una de estas etapas, con el fin de mantener todas las variables que las rigen bajo control.
Quienes ejecutan esta actividad deben desarrollar la capacidad de visualizar situaciones especiales, las cuales deben tenerse presente en el mapa mental de cada operación y cuando se detecten vayan directamente al punto.

Jaulas forman parte de los cerramientos. Los trabajadores toman los pollos por las patas, caminan un poco y los introducen perpendicularmente en las jaulas, teniendo dos cuidados:

está desocupado.
Cargadores atrapan las aves y caminan con ellos manteniendo los brazos rectos y sin moverlos, 20 metros en algunas ocasiones, donde se estacionan los camiones. Las jaulas están al lado de la plataforma, que una vez se pesan se van subiendo: manual y /o automáticamente a los camiones.
Si las jaulas se llenan dentro de las naves, una vez completada la carga se desplaza manualmente y/o automáticamente.
Las jaulas se conectan entre sí, como vagones de un tren arrastrados por un winche operado a control remoto dejándolos cerca de un transportador reversible que los sube a la plataforma, en este reversible se los sube a la plataforma.
En ese lugar se encuentran dos grupos de dos operarios, que colocan las jaulas sobre carritos especiales hasta alcanzar la altura de 8 o 9 jaulas. Una vez completado las van llevando al sitio más próximo al camión donde se inicia la organización de estos.


En climas calurosos algunas empresas mojan los pollos para refrescarlos en las granjas.
Finalizada esta actividad los vehículos deben partir de inmediato hacia la planta procesadora, para disipar el calor evaporativo que se incrementa gradualmente.

Los fabricantes de camiones destinados a esta labor cotidiana ofrecen plataformas con todas las mejores tecnologías posibles para que los pollos se conserven dentro de la zona de confort, independientemente de las condiciones ambientales que llegan a niveles extremos.
Parámetros de Referencia:
Climas calurosos: 0,05% hasta 0,10% del total de pollos procesados. Ejemplo: 100.000 aves.
Los pollos muertos - DOA-, entre 50 y 100 animales.
Climas fríos: 0,05%. Ejemplo: Proceso: 100.000 pollos/día.
DOA: Máximo 50 pollos
Es muy importante que los operadores de estos camiones recuerden que transportan una carga viva, frágil. Por lo tanto, deben disciplinadamente cumplir las normas establecidas por las empresas dueñas de los pollos:
Reducir la velocidad en las curvas para que la acción de la fuerza centrífuga se disminuya, evitando que las alas se golpeen con las paredes internas de las jaulas.
Reductores para bajar la velocidad con el propósito que, al pasar el vehículo sobre ellos, la plataforma se levante lo mínimo posible. De esta manera, los golpes que reciben los animales en las espaldas también disminuyen.

Clima cálido, después de pesados los camiones pasan a una estación de lavado similar a las que existe en las granjas.
Dependiendo del tamaño de los vehículos y la carga el tiempo oscila entre 30 segundos y 1 minuto.
Seguidamente se trasladan a la zona de espera donde debe existir una adecuada infraestructura y efectiva para extraer el calor evaporativo.

El monitoreo de las temperaturas y humedades relativas – HR- de esta área reviste la mayor importancia, con el fin de que las aves estén tranquilas esperando su turno de procesar.
En el mercado se consiguen sistemas sofisticados que permiten conservar los parámetros de control de estas variables 22ºC a 26ºC- HR: 65%, Cada empresa establece estos valores.

A esta área llegan las aves en jaulas o en contenedores, durante este traslado los animales permanecen dentro de sus recipientes. Para ello se coloca una rejilla que impida la salida de los pollos de las jaulas.
De esta manera, no se pierde tiempo capturando las aves que caminan por el piso de esta sección.
El puesto de colgado de pollos vivos debe tener entre otros aspectos ergonómicos los siguientes:
Dos tipos de luces:
Blanca que se utiliza cuando la planta no está funcionando y/o durante su limpieza. Azul cuando se están procesando aves. Actualmente se consiguen bombillos con doble filamento, que facilita su operación.
Adecuada renovación del aire que reciben los operarios en la parte superior de la espalda y del cuello, evitando que el polvo que tienen las aves en sus plumas y piel, no le llegue a su rostro impidiendo la visión.

Al tomar los pollos, sacarlos de las jaulas o del contenedor, los trabajadores cuelgan los animales en los ganchos formando un ángulo de aproximadamente 45 grados, condición que se denomina Distancia Normal de Trabajo.
Este detalle permite que el personal haga su labor con el menor desgaste posible, aumentando su rendimiento, medidos en pollo / hora- trabajador, lográndose hasta 1.800 aves/hora-operario.
Este acercamiento de las aves a los ganchos representa un descanso de 1 hora durante el turno.

La guía metálica detrás de los ganchos debe estar en contacto permanentemente con ellos. De esta manera, el personal siempre tiene los ganchos a la misma distancia.
Los ganchos no deben estar partidos ni doblados
Los ganchos deben estar completos y conectados entre sí, a fin de asegurar la misma distancia en cada una de las operaciones que lleva a cabo.
Todos los ganchos deben estar llenos
Las patas de los pollos deben llegar hasta el fondo de los ganchos suavemente, evitando se dañen las patas fracturándolas.
Dependiendo del tipo de gancho, estos pueden reformarse para que sean expandibles en el trayecto que recorren las

El desplazamiento de los troleys – ruedas-, debe hacerse sin sobre salto. En estas condiciones no se altera la tranquilidad que deben tener las aves hasta llegar al aturdidor.
El tiempo del tramo último del colgador y la entrada al aturdidor debe oscilar entre los 20 segundos y 30 segundos, impidiendo que la sangre se almacené en las alas. Además, cubierto con una especie de túnel fabricado con lona plástica.
El masajeador de pechugas: Debe estar rígidamente instalado permitiendo ajustarlo horizontal y/o verticalmente según el peso promedio de los animales.
Objetivo; Una vez los animales ubicados en los ganchos, son soltados y no deben aletear, porque la pechuga entra inmediatamente en contacto con esta superficie que puede ser plana o circular.
Si esta condición especial no se cumple al aletear los pollos, se comienza a depositar más sangre en las alas. Estas cantidades extras de sangre afectan la calidad Grado A de las alas.
Los puntos críticos a revisar continuamente para que los ajustes de este equipo se realicen acorde con el peso promedio vivo, sexo, etc. son los siguientes:
Eléctricos: Frecuencia, tipo de onda, voltaje, amperaje
Tiempo dentro de la tina: 10 a 12 segundos
Altura agua en la tina: el nivel de agua debe estar 3 centímetros antes de que el pescuezo se conecte con la pechuga.
Este detalle garantiza que el agua nunca tocará la pechuga, conformada por dos músculos pectorales que funciona antagónicamente: Tipo bisagras.
Aspecto importante: Hasta donde las circunstancias lo permiten, el recorrido entre el colgado y la entrada al aturdidor debe tener la menor cantidad de giros o cambios de sentido, con el fin de no alterar el estado de quietud que deben conservar los animales antes de ingresar al gabinete del aturdidor
Como la corriente son impulsos y contracciones, se favorece la ocurrencia de ruptura de vasos sanguíneos formándose hemorragias y fracturas de los huesos frágiles que conforman el tórax.




Prechoque: la entrada de los pollos a la tina debe ser libre como acontece en las escaldadoras.
El nivel del agua de la tina debe permanecer siempre a la altura inicial. Algunas plantas han establecido que las cabezas de los pollos deben estar separadas más o menos 2,5 centímetros de la lámina perforada a través del cual se distribuye la corriente.
En términos prácticos, un buen aturdido se confirma cuando los pollos dejan la tina del aturdidor vibrando inicialmente –fase tónicay luego se relajan completamente – fase clónica-.
En esta condición de quietud debe ingresar a las guías de los matadores automáticos –killer-. Este tiempo oscila entre los 10 y 12 segundos, donde los animales recuperan la frecuencia cardiaca completamente.

Control de Proceso: 30 Aspectos
Puntuales a Evaluarse durante la Prefaena hasta el Sacrificio
DESCÁRGALO EN PDF
Sara Llorens Cardona Sales & Technical Manager Aviagen SAU
Cuando recibimos un lote de reproductores, empieza desde ese momento una nueva etapa en la que se deben de tener claras las fases que hay durante la recría para poder proporcionar un manejo óptimo a los animales y poder lograr el objetivo de obtener el mejor desarrollo, preparando a los animales para la madurez sexual, juntamente con una buena condición corporal y uniformidad del lote.


Manejar la reproductora en la etapa de la recría de acuerdo con el perfil objetivo de crecimiento permite que las aves logren un rendimiento óptimo en su vida reproductiva, al asegurar que crezcan y se desarrollen correctamente.
Los órganos y tejidos se desarrollan en diferentes etapas, por lo tanto, el responsable del lote debe considerar y conocer las prioridades de las aves respecto a su crecimiento y desarrollo en cada etapa.
Se debe ajustar el manejo y las cantidades de alimento de acuerdo con las necesidades del ave y en función de la etapa que nos encontramos.


¿En cuántas fases se puede dividir la recría y qué es lo que sucede en cada una?
¿Qué sucede en esta fase?
Es esencial proporcionar un buen arranque a los pollitos reproductores cuando llegan a la granja para su salud y bienestar, uniformidad, rendimiento y desarrollo del lote.
¿Qué se debe de tener en cuenta en esta etapa?
Las aves deben de arrancar en las mejores condiciones posibles y llegar al peso estándar a las 4 semanas trabajándolo desde la primera semana de vida.
Va en contra de la uniformidad llegar a las 4 semanas con un peso muy superior al estándar, ya que muchas veces como respuesta a eso se tiende a restringir el alimento para reducir el crecimiento, por lo que no se está administrando los consumos necesarios para cumplir las necesidades de las aves, el aporte de aminoácidos, vitaminas, energía, proteína… será menor y como consecuencia también será menor su desarrollo general.
¿Qué sucede en esta fase?
En esta fase debemos de aprovechar que el esqueleto aún no está formado completamente para recuperar las aves con un peso inferior a la media, siendo una fase de control de pesos.
¿Qué se debe de tener en cuenta en esta etapa?

A las 4 semanas tenemos el esqueleto formado un 50% y existe un rápido desarrollo de los sistemas inmunológico, cardiovascular, digestivo, esqueleto y del plumaje.
A las 10 semanas tenemos el esqueleto formado un 90%, habiendo una continuación del crecimiento y desarrollo de los sistemas.

Figura 1. Ajuste de los futuros objetivos de peso corporal hacia los 63 días (9 semanas) de edad.
corporal
Pesada
Estándar
Liviana
Clasi cación del lote
Cuando tengamos aves con peso inferior o superior al objetivo, la meta es ajustar el perfil de crecimiento de manera que las aves alcancen el objetivo gradualmente hacia las 9 semanas de edad (63 días).
Las raciones de alimento nunca se deben reducir, pero si es necesario, se puede retrasar el siguiente incremento de la ración con el fin de lograr un nuevo perfil.
¿Qué sucede en esta fase?
En esta fase ya tenemos el esqueleto formado al 100% y el objetivo es evitar que las gallinas se engrasen y engorden en exceso, es una fase de mantenimiento.

¿Qué se debe de tener en cuenta en esta etapa?
Debemos de reevaluar el peso de la población en relación al objetivo, como en la anterior fase.
Si tenemos aves que continúan con pesos inferiores o superiores al objetivo a las 9 semanas de vida, se deberá de trazar un nuevo perfil de crecimiento de manera que las aves alcancen el objetivo gradualmente hacia las 15 semanas de vida (105 días).
Para lograr esto, se debe aumentar la ración o adelantar el próximo incremento en aves con pesos inferiores.
En aves con pesos superiores si es necesario se puede retrasar el siguiente incremento de la ración con el fin de lograr un nuevo perfil, pero nunca reducir la ración.

Pesada
Estándar
Liviana
Figura 2. Ajuste de los futuros objetivos de peso corporal cuando el promedio está por debajo, sobre o por encima del objetivo a los 63 días (9 semanas) de edad.
Clasi cación del lote
La mejor opción para rentabilizar su granja



Trampillas COPILOT AIR:
Diseño innovador para un guiado perfecto del flujo de aire, máximo control en ventilación mínima.
Fabricado en espuma de poliuretano de alta calidad.

Extractores COPILOT VENT:
Aseguran un óptimo rendimiento al mínimo consumo eléctrico y una gran durabilidad. Nivel de ruido muy bajo.

Motores de Trampilla:
Robustos, seguros, de alta calidad y precisión a un precio muy competitivo.
Recuperadores de calor IC10:
Un producto de alta Eficiencia Energética para la mejora del Bienestar Animal.
Máximo ahorro de energía mejorando la calidad del ambiente en la nave avícola.







¿Qué sucede en esta fase?
En esta fase se desarrolla todo el aparato reproductivo, la deposición grasa (%) y el desarrollo de los caracteres sexuales secundarios, es una de las fases más importantes a tener en cuenta.

¿Qué se debe de tener en cuenta en esta etapa?
El objetivo en esta fase es mantener una correcta uniformidad del lote y preparar a los animales para la transición a la granja de producción y el inicio de producción de huevos, de esta manera aseguraremos un buen rendimiento del lote.
Es importante llegar a esta fase con una buena condición corporal y con pesos similares al objetivo para poder realizar incrementos de pienso más intensos que serán de ayuda para preparar a los animales de cara a la producción y a los futuros estímulos que van a recibir.
Si se llega a esta fase con pesos muy superiores al objetivo no se podrán realizar estos incrementos de pienso, solamente se podrá realizar si el estado corporal de los animales nos lo permite y los piensos utilizados siguen las recomendaciones estrictamente marcadas por la casa de genética.
En esta fase debemos de reevaluar el peso de la población en relación al objetivo como en la anterior fase, la supervisión frecuente y el registro del peso corporal y la uniformidad son herramientas vitales de manejo.
Si tenemos aves con pesos corporales inferiores al objetivo a las 15 semanas (105 días), se deberá de trazar un nuevo perfil de crecimiento de manera que las aves alcancen el objetivo gradualmente hasta el momento del estímulo de luz, no después.
En el caso contrario, si tenemos aves con peso corporal superior al objetivo a las 15 semanas (105 días) se deberá trazar una nueva curva de peso paralela al objetivo original. El manejo se debe centrar en reducir al mínimo las consecuencias de esta situación.

Las aves no pueden llevarse al peso objetivo estándar si tienen sobrepeso en esta etapa, esto daría como resultado una pérdida en la condición física afectando negativamente a la producción.
El desarrollo de características sexuales secundarias, tales como la separación de los huesos pélvicos en las hembras y aumento de la intensidad del color facial en ambos sexos son buenos indicadores del progreso de la madurez sexual del lote.
Figura 3. Ajuste de las curvas de peso corporal si las hembras tienen pesos inferiores (livianas) o superiores (pesadas) al peso objetivo a las 15 semanas (105 días) de edad.
Pesada
Para conseguir aves preparadas y con una variación mínima en el inicio de la madurez sexual se tiene que realizar un buen manejo enfocado a cada fase de la recría.
Hay un objetivo común en todas las fases que es la uniformidad, por eso debemos de dedicar especial atención al manejo de la uniformidad del lote mediante las selecciones, al trabajo semanal de pesaje y control de pesos.
A medida que las aves van creciendo el coeficiente de variación irá en aumento a causa de las diferentes respuestas individuales de las aves y factores tales como cambios ambientales, manejo en la iluminación, vacunaciones, enfermedades, cambios de pienso, etc.

Si no se realiza un buen manejo estas respuestas individuales pueden comprometer la uniformidad del lote y como consecuencia el rendimiento en producción.
Liviana Estándar
PESO MEDIO

En las siguientes gráficas se observa claramente la evolución de la variación de lotes sin clasificar y lotes con clasificación, observándose a las 15 semanas (105 días) una diferencia clara de desviación.
4.
Día 1
PESO MEDIO
Día 21
Evolución de la variación en lotes sin clasi car
PESO MEDIO
Evolución de la variación en lotes con clasi cación
PESO MEDIO Día 105
¿Qué preguntas nos debemos de hacer para entender la importancia de la uniformidad?
¿Por qué es tan importante la uniformidad?
Si se logra tener aves en estado fisiológico similar, éstas responderán de manera similar a los factores de manejo.
¿Qué se obtiene con estas respuestas similares?
El control sobre el éxito productivo y de bienestar de los animales.
¿Cómo se logra?
Seleccionar las aves y dividirlas en subgrupos para así lograr el control sobre los pesos corporales con coeficientes de variación mínimos y crecimientos uniformes acorde con los objetivos de peso marcados.
¿A quién se selecciona?
Se debe de seguir las mismas pautas tanto en machos como en hembras.
¿Cuándo se debe de empezar a seleccionar?
Se debe empezar lo antes posible. Es decir, desde la llegada de los animales a la granja.




Para trabajar la uniformidad estas son las edades en las que se recomienda hacer una selección total de los animales:
Primer día Distintas edades 4-5 semanas (transición)
Puntos importantes para realizar una buena selección:
Empezar a seleccionar lo antes posible
El primer día es importante separar los animales que sean de distinto lote. Es decir, distinta edad de las abuelas, y mantenerlos separados hasta la semana 4, como mínimo.
Realizar 2 o 3 parques y mantenerlos hasta el traslado. Los parques se deben de trabajar a diario y llevar un control con registro de pesos.
Calibrar y revisar los dispositivos de pesaje que se utilicen de manera rutinaria para evitar confusiones en los pesos
8-9 semanas 12-14 semanas 16-18 semanas
En la última selección que se realice es importante que no se mezclen los animales y se mantengan los parques hasta el momento del traslado para poder agrupar en la nave de producción animales lo más similares posible. Las aves que se encuentren en el parque de las pequeñas tendrán otras necesidades y otro metabolismo respecto al resto.



El momento de la transición del pienso a granulado y en aéreo, sobre la semana 4 de edad, es un momento crítico para la uniformidad, por eso es importante realizar una selección unos días después de ese momento para evitar que algunas aves se queden retrasadas y no sean capaces de adaptarse al nuevo manejo de alimentación afectando a la uniformidad del lote.
El objetivo es lograr un lote lo más uniforme posible y preparado con una madurez sexual similar, para conseguir un buen rendimiento del lote en producción. Para ello, es necesario dedicarle tiempo y constancia en todas las fases de la recría y empezar desde el primer día de vida de los animales, trabajando la uniformidad y la condición corporal en cada momento.
La uniformidad es la clave para asegurar un buen rendimiento del lote en producción.

Ubicada a solo 2 km de Mollerussa, en Lleida, esta granja avícola familiar se ha consolidado como una referencia en el sector avícola, evolucionando a lo largo de generaciones y adaptándose a los desafíos contemporáneos.
A través de la creación de las últimas instalaciones, con el apoyo crucial de Comavic, han logrado mantenerse a la vanguardia en términos de eficiencia y bienestar animal.


Apenas dos años después, en 1974, realizaron una ampliación signi cativa, añadiendo otra instalación para la recría de pollitas
La historia de esta granja avícola se remonta al año 1972, cuando el padre del actual propietario decidió montar la primera granja de recría de pollitas comerciales.


El clima en Mollerussa, especialmente en invierno, presenta un reto significativo debido al frío intenso y la niebla densa.
Además, el verano no es menos desafiante, con temperaturas que alcanzan hasta 41- 42 grados, lo que hace vital contar con sistemas de ventilación y refrigeración eficientes para asegurar el bienestar de las aves.

Un punto de in exión se produjo en 1990-91 cuando la familia decidió cambiar su enfoque a la cría de reproductoras pesadas. En ese momento, todo el proceso era manual, desde los ponederos de madera hasta la alimentación de las 18,000 reproductoras.

Finalmente, gracias al apoyo de Comavic, en febrero de este mismo año se inauguraron dos nuevas granjas, incrementando la capacidad total a 40,000 gallinas.
La expansión continuó en 1981 con una nueva explotación dedicada a la recría.

En el pasado, Hortensi había colaborado con varias empresas locales debido a su facilidad y proximidad. Sin embargo, encontró que sus sistemas eran complejos y difíciles de implementar, por lo que decidió explorar otras opciones.
Fue entonces cuando comenzó su asociación con Maker Farms, reconocida por la calidad de sus productos y servicio al cliente, instalando diversos equipos en su granja.
La innovación no se detuvo, y en 2003 construyeron una nueva nave, alcanzando un total de 30,000 gallinas.

Tras la adquisición de Maker Farms por parte del grupo Iberian Ventures, Hortensi está convencido de que Comavic es un socio estratégico fundamental en el sector avícola.
“Si algo funciona y cumple con las expectativas, nunca voy a cambiar. Comavic se ha ganado con creces mi confianza”, asegura Hortensi.
Esta fidelidad se debe en gran parte al excelente servicio y apoyo post venta proporcionado por Comavic
El productor nos confiesa que han estado muy presentes “antes, durante y después de la puesta en marcha de la instalación”.
“El trato recibido por ellos fue fenomenal, siempre nos han ayudado en todo momento. Están siempre a un toque de teléfono”, señala.
El sistema de alimentación elegido es Chainovation para las gallinas y Matrix para los Gallos, de la empresa VDL Agrotech de la que Comavic es distribuidor para España
El comedero Matrix de VDL Agrotech, permite una alimentación eficiente sin desperdicio, permitiendo que cada animal disponga de su ración al mismo tiempo
Este comedero innovador optimiza la eficiencia alimentaria y contribuye al bienestar y rendimiento óptimo de las aves en la granja.

“Las gallinas comen de fábula”, afirma Hortensi, destacando también la precisión lograda mediante la automatización.


En cuanto a los ponederos, la familia ha decidido utilizar los productos de Comavic & Maker Farms, una elección motivada por su eficiencia y grandes resultados a lo largo de los años.
El ponedero instalado es Jansen, ya que tiene una alta aceptación por parte de las gallinas, minimizando el huevo en suelo y proporcionando huevo limpio y sin fisuras.

“El diseño nos parece excelente. Gracias a la facilidad de montaje y la simplicidad de su diseño, que evita rincones difíciles, podemos limpiar y desinfectar de manera muy sencilla”, explicó el productor.
La durabilidad de estos ponederos es especialmente destacable, VDL Jansen, gracias a sus alfombrillas resistentes que ofrecen una protección sólida y prolongada para las gallinas reproductoras, asegurando un entorno higiénico y cómodo para la producción continua de huevos de alta calidad.
La iluminación HATO, instalada en las nuevas granjas, permite regular la intensidad y duración de la luz, creando un ambiente óptimo para las aves y reduciendo los costos operativos.
Este sistema ha superado ampliamente las prestaciones de los antiguos fluorescentes utilizados en las granjas anteriores, permitiendo una flexibilidad total a las necesidades que presenta en cada momento la nave.
La implementación del transportador de huevos FlexBelt ha mejorado significativamente la eficiencia en la recolección de huevos, reduciendo el número de huevos rotos y optimizando el proceso general.
Además, la facilidad de limpieza del transportador ha sido un factor determinante en su elección.

Fotografía 3. Transportador de huevos FlexBelt conectando ambas naves
Los paneles de refrigeración
Munters han demostrado ser esenciales durante los calurosos veranos en Mollerussa, manteniendo una temperatura ideal en las naves y asegurando la salud y productividad de las gallinas, incluso en las condiciones climáticas más extremas.
Estos sistemas no solo regulan eficazmente la temperatura, sino que también contribuyen a mantener un ambiente confortable y propicio para el desarrollo óptimo de las aves.

Además, la instalación de sistemas de control ambiental Tuffigo ha llevado la gestión de la granja a un nivel superior.
Estos sistemas permiten un monitoreo y control precisos de la temperatura interior y exterior, la humedad relativa y los niveles de CO₂, aspectos cruciales para garantizar el bienestar y la salud de las aves.
La capacidad de ajustar estos parámetros según las necesidades específicas de cada etapa de producción optimiza la eficiencia operativa y la rentabilidad de la granja en general.
Con una trayectoria marcada por la innovación y el esfuerzo constante, la familia planea seguir colaborando con Comavic, confiando en sus productos y servicios para mantener y mejorar sus estándares de producción.
La combinación de tecnología avanzada y el apoyo continuo de Comavic asegura un futuro prometedor para esta granja avícola familiar, un ejemplo de adaptación y progreso en el sector avícola de Lleida.

De Abuelos a Nietos: 50 Años de avicultura familiar con Comavic DESCÁRGALO EN PDF


Asesoramos, actualizamos y modernizamos su explotación
Optimice el consumo energético de su granja
Mejore el bienestar de sus animales
Maximice el rendimiento de su explotación

A medida que nos acercamos al verano, es fundamental anticiparse al ascenso de temperaturas.
No espere más e instale nuestros equipos a tiempo, garantizando así un ambiente fresco y confortable para mejorar los resultados de su granja.



Tel: 977 75 54
comavic@comavic.com / correo@maker-farms.com
Adriano Bailos Consultor en Incubación industrial

HGrandes cambios se han producido en el mundo de la incubación industrial desde la llegada de la monoetapa, máquinas controladas por termostatos y con paneles analógicos han dado paso a modernas máquinas equipadas con medidores de temperatura de embriones, controladores de CO₂, lecturas computarizadas y otras tecnologías.
ablar de costes de producción, en el sector avícola de puesta, como en cualquier otro, es parecido a la búsqueda del “santo grial”. Todo el mundo habla de ello, pero no existe un “cáliz sagrado”, (concreto y universal), que proporcione la eterna “juventud” (solución o equilibrio).



Junto a esta evolución también tenemos cambios en el comportamiento de los embriones, cada año las líneas genéticas van buscando un pollo más robusto, con mejor ganancia de peso y menor conversión alimenticia, haciendo cada vez más difícil el proceso de incubación.

Temperatura:
Para definir los parámetros de temperatura tenemos que considerar el desarrollo térmico no lineal del embrión.
Por otro lado, en la planta de incubación vemos embriones más sensibles y más susceptibles a pequeños estándares incorrectos de temperatura, CO₂ y humedad, al observar este escenario vemos que la gran pregunta es,
¿estamos preparados para incubar estos embriones modernos para proporcionar un polluelo que nos permita aprovechar todas las mejoras genéticas? ¿ Cuáles son estos parámetros ?.
En este artículo pretendo explicar de forma sencilla y directa qué se debe tener en cuenta a la hora de definir correctamente los programas de temperatura, humedad, CO₂ y volteo, incluyendo sugerencias de programas universales que se pueden utilizar en plantas de incubación monoetapa de todo el mundo.

Cuando iniciamos la incubación el embrión depende completamente del calentamiento de la incubadora para desarrollarse y a medida que pasan los días de incubación esta dependencia disminuye con el inicio de la generación de calor por el embrión.

Independientemente de la fuente de calor, debemos asegurarnos de que el embrión se mantenga siempre a una temperatura estable entre 37,5 ºC y 38,3ºC, para ello debemos utilizar una temperatura programada de 37,9ºC en el sensor del embrión desde cero días hasta el 4º - 5º día de incubación.

Después del 5º día debemos fijar la temperatura del embrión en 37,8ºC hasta el día 17 y a partir del día 18 este parámetro cambia a 37,7ºC y continúa hasta la transferencia.
En las incubadoras que tienen sensor de embrión no hay necesidad para hacer esto con diferentes programas de alta y baja fertilidad. En incubadoras que funcionan por programa SIN sensor de embriones, lo ideal es considerar 0,11ºC por encima del programa original en lotes con infertilidad mayor al 15%.
Cuando se habla de parámetros de incubadoras de una sola etapa, es imposible separar el control de CO₂ del control de humedad.
Para configurar un programa de temperatura para incubadoras que no tienen sensor de embriones, lo ideal es utilizar inicialmente el programa sugerido por el fabricante, para luego realizar un control térmico de la incubadora midiendo la temperatura del embrión a 6, 10, 12, 14, y 18 días para evaluar si es necesario realizar algún cambio.
Estos dos parámetros están directamente relacionados porque toda la humedad expulsada por los huevos durante el intercambio gaseoso depende de la renovación del aire de la incubadora a eliminar.
A su vez, todo el intercambio de aire en la incubadora depende de la apertura del damper y lo que determina la apertura del damper es el programa de CO₂. Los cambios normalmente son necesarios porque el fabricante tiene un modelo para todo el mundo, pero hay particularidades como el clima donde está instalada la planta, tipo de aire acondicionado, altitud, entre otras que interferirá en el funcionamiento del equipo.
Por lo tanto, por regla general, cuanto menor sea el CO₂, más se abre el dumper, mayor es la renovación y menor será la humedad.


Está científicamente comprobado que trabajar con mayores niveles de CO₂ en los primeros días de incubación es beneficioso para el embrión, sin embargo es muy importante tener un programa que permita una pérdida mínima de humedad del 11% hasta el traslado.
De esta manera, para determinar el programa de CO₂ es necesario saber si la planta de incubación cuenta con un sistema de deshumidificación del aire o si está sujeta a la humedad del ambiente externo.
Más del 95% de las incubadoras monoetapa de nueva construcción no cuentan con deshumidificación del aire, ya sea por no estar diseñado durante la construcción o porque tiene un alto costo de operación.
Por lo tanto tenemos dos opciones para determinar el programa de CO2 :
Determinar un programa intermedio de CO₂ para utilizar durante todo el año
Determinar dos programas anuales, uno para épocas secas y otro para épocas de lluvias.
El CO2 alto al inicio de la incubación es importante para el embrión, pero una pérdida de humedad muy baja es extremadamente dañina, es decir, entre trabajar con CO2 alto y perder poca humedad o trabajar con CO2 bajo y perder la humedad correcta, NO HAY DUDA, opte por la segunda opción.
Recordando que en las máquinas monoetapa no controlamos el set point de humedad sino el mínimo (ya que en las incubadoras no hay deshumidificadores), por lo tanto debemos controlar el mínimo para evitar una humedad demasiado baja que pueda dañar a los embriones.
Por ello, no hay necesidad de un programa de humedad, que simplemente determine una humedad mínima de 21,1ºC en el bulbo húmedo.
Sabemos que el volteo es muy importante en el proceso de incubación, especialmente en los primeros 8 días de incubación donde hay un alto riesgo de que el embrión se adhiere a la membrana interna y muera.

Las nacedoras siempre han sido de una sola etapa, pero han sufrido cambios importantes en los últimos años, como que ya no se enfrían mediante ventilación y lo hacen mediante serpentines de agua helada.
El trabajo ha demostrado que un volteo más frecuente (cada 15 minutos) en estos primeros días puede reducir la mortalidad inicial y mejorar la eclosión.
Lamentablemente los sistemas de volteo de las máquinas actuales no soportan una frecuencia tan alta durante toda la incubación, corriendo el riesgo de dañar el equipo, en este caso la sugerencia es trabajar con un volteo más frecuente cada 15 o 30 minutos durante los primeros siete días y después del octavo día de incubación, repetir este proceso cada 60 minutos.
Mientras tanto, se ha modificado la apertura de dumpers y los intercambios de aire que eran controlados por temperatura.




⚫Todos los equipos automatizados para plantas de incubación
⚫Miraje, Vacunación INOVO Technolog ía
⚫Soluciones para incubadoras grandes, medianas y pequeñas
⚫Construcción de acero inoxidable fuerte y resistente
⚫Nuevas tecnologías de proceso de OAC que evitan las micro fisuras y la contaminación y mejoran el porcentaje del nacimiento

INOVOVAC con tecnología V.I.S.A Detección sin contacto de huevos volcados y rotos


TECNOLOGÍAS AVANZADAS Y INNOVADORAS
Reduce la contaminación y mejora la Eclosabilidad

• NECTRA LIFE CANDLING: Detecta embriones vivos y muertos dentro del huevo.
• ACUTE DETECCIÓN AL REVÉS: Detección sin contacto de huevos al revés y sin rodar los huevos. Mejora de la incubabilidad entre un 1 y 2 %
• SMART Tecnología de llenado ordenado OAC directamente en bandejas de incubación, evita rodamientos y golpes en las cintas : Previene las fisuras de los huevos así como la contaminación debido a la fricción en la cinta transportadora, y mejora el porcentaje del nacimiento
• OVOSEX1 : sexado no invasivo en el huevos fertil (ponedora)

Encuéntrenos en el stand N°C65 del 17-19 Septiembre en SPACE









Tecnología NECTRASCAN Y NECTRALIFE Muy alta precisión, identifica embriones




ACUTE : detección sin contacto de huevos al revés y detección de los huevos fisurados sin rodar
Pasó de trabajar exclusivamente para controlar O₂ x CO₂ a otro cambio en los parámetros de eclosión orientado a incubar huevos de líneas genéticas modernas, fue la reducción de la humedad, antiguamente se trabajaba con temperaturas de bulbo húmedo cercanas a los 32,2ºC y actualmente es muy común trabajar entre 28,9ºC y 30,0ºC.

Tenemos que considerar que la temperatura en la nacedora está controlada para mantener cómodo al embrión/pollito.
Aumentar o disminuir la temperatura en este punto del proceso no “avanzará” ni “retrasará” el nacimiento, pero ciertamente puede cambiar la calidad de las aves.
Para determinar un programa de temperatura de la nacedora, se debe:
realizar una medición térmica de la cloaca durante el nacimiento y adaptar la temperatura ambiente de la máquina para mantener a las aves cómodas con una temperatura corporal entre 39,4ºC y 40,6ºC.
Para tener un punto de partida, dejo una sugerencia estándar para un programa de temperatura que se puede usar inicialmente hasta que la incubadora pueda crear su propio programa personalizado en la Tabla 1.
Programa general de temperatura de nacedoras
1. Programa general de temperatura en nacedoras

La primera regla para determinar un buen programa de O₂ x CO₂ es comprender que las aves que nacen con respiración pulmonar requieren una concentración de CO₂ inferior a 3000 ppm.
Por lo que incluso podemos configurar un programa que aumente el CO₂ inmediatamente después de la transferencia, apuntando mejor a una ventana de nacimiento.
Pero después de que el 20% de las aves hayan eclosionado no podemos superar las 3.000 ppm.
En la Tabla 2 se muestra un programa general que se puede utilizar en todo el mundo sin preocuparse por sobrecargar a las aves que nacen con una alta concentración de CO₂.
2. Programa de CO2 en las nacedoras
Como la humedad en las incubadoras es un elemento muy difícil de controlar, cuando hay por ejemplo el pico de nacimiento de las aves, la humedad relativa puede llegar cerca del 100%, ya que no podemos controlar la humedad máxima, entonces debemos controlar la mínima,
Para mantener un ambiente agradable a las aves después de su nacimiento, es importante que la humedad después del nacimiento de las aves esté alrededor del 50% al 60%,
por lo que en máquinas controladas por bulbo húmedo podemos trabajar a 30 ºC, evitando la deshidratación de las aves.
¿Cómo definir correctamente los parámetros de incubación modernos?
DESCÁRGALO EN PDF

Uno de los parámetros claves en producción de huevos comerciales es, sin duda, el tamaño de huevo.
Es innegable que la producción de huevos de gramaje alto puede tener contraprestaciones tales como una degradación precoz de la calidad de cáscara, la pérdida de huevos acumulados por un arranque tardío, un deterioro del índice de conversión o una mayor mortalidad acumulada.
Sin embargo, incluso teniendo en cuenta todo esto, los lotes de huevos de gramaje alto pueden seguir siendo económicamente viables.
Esto es especialmente cierto en aquellos países donde el mercado paga un precio diferencial muy alto por estos huevos de más gramaje como el español.
El tamaño del huevo tiene un componente genético ya que es un parámetro con una alta heredabilidad.
Sin embargo, modificaciones en el manejo del ave y la nutrición tienen un impacto incluso mayor que la genética de la gallina.
El objetivo de este documento es clarificar los puntos claves para adaptar la producción de huevo a la exigencia de mercados con fuerte demanda de huevos de calibre alto.
El tamaño de huevo está basado en tres pilares:

Sin embargo, si el crecimiento se produce en la parte final de la recría no es igualmente efectivo, ya que esencialmente durante esas semanas se deposita principalmente grasa.
Por tanto, no se desarrollará una estructura corporal musculoesquelética adecuada capaz de soportar un ciclo productivo largo y rentable, si no que solamente se obtendrá un ave se obtendrá ave simplemente pesada.
Tamaño de ave y tamaño del huevo
El peso corporal del ave a la edad de maduración sexual tiene una correlación directa con el peso de los huevos producidos. De forma simple, las aves con pesos adecuados a esta edad tienen un mejor perfil productivo a lo largo de su vida y se adaptan mejor a los diferentes requisitos de producción en relación con el tamaño de huevo deseado.
Se estima que por cada 45 g por encima del estándar a la semana 18 de vida, se aumenta en 0,5 g en el peso del huevo acumulado.
Se sabe que el período clave para el desarrollo de la carcasa del ave alcanza su máximo a la 6a semana de vida (como se muestra en la Figura 1).

La única manera de monitorear el desarrollo corporal del lote es a través del pesaje sistemático de una muestra significativa de aves.
Los pesajes del lote deben iniciarse al final de la primera semana de vida, repitiéndolo semanalmente.
En el caso de las gallinas en jaula, se deben pesar siempre las mismas jaulas de diferentes zonas de la nave para hacer un mejor seguimiento.
En recrías de sistemas alternativos, las aves deben ser seleccionadas de diferentes partes de la nave y pesarse con la misma regularidad que en las gallinas en jaula.
Además del peso corporal, también debe calcularse la uniformidad del lote. Esta es igualmente importante en la evaluación del desarrollo del lote y el rendimiento productivo futuro.
El cumplimiento del pesaje semanal facilita la identificación de los factores responsables de ralentizar el desarrollo corporal del lote. Igualmente permite poder hacer cambios de alimento balanceado de acuerdo con el desarrollo del ave, cambiar el manejo de tiradas de alimento aplicado al lote o promover cambios nutricionales en el alimento balanceado, ver Imagen 1.

Imagen 1. Presentación de alimento balanceado.

Estimulando el consumo, una herramienta esencial
La estimulación del consumo de alimento debe comenzar tan pronto como las aves entren en las naves de recría, teniendo en cuenta que el peso corporal de las aves ya en la 6a semana estará directamente relacionado con el peso de los huevos producidos.
Por lo tanto, tener un buen comienzo es fundamental e influirá en todo el perfil productivo del lote. Para lograrlo debe tenerse en cuenta la presentación del alimento.

Un error que suele cometerse cuando nos encontramos con lotes que tienen déficit de peso y no alcanzan la ingesta de alimento balanceado diaria es aumentar el número de tiradas de alimento.
El objetivo de esto es activar a las aves para comer debido al estímulo sonoro de las cadenas de alimentación y por la distribución de alimento fresco con partículas groseras de grano, las preferidas de las aves.
Es esencial vaciar los comederos, preferiblemente diariamente.
La aplicación del protocolo de vaciado de los comederos se puede hacer a partir de la 4a semana de vida, cuando los animales ya ingieren suficiente volumen de alimento para permitir el vaciado, sin perjudicar a la cantidad total de alimento que el lote debe comer diariamente.

El vaciado tiene dos objetivos principales:
Forzar la ingesta de los finos del alimento balanceado, permitiendo una alimentación completa a los animales.
Ayudar al desarrollo del sistema digestivo del ave y particularmente del buche y la molleja.

La forma más fácil de hacer el vaciado es, simplemente, dejar que las gallinas consuman hasta dejarlos completamente vacíos antes de hacer un nuevo reparto de alimento. Cuando los comederos se vuelven a llenar debe hacerse en dos pasajes consecutivos, espaciados 30-45 minutos, para asegurarse de que todas las gallinas coman y no sólo las dominantes.
Consulte la Guía de manejo de H&N para obtener más información sobre las densidades recomendadas para diferentes tipos de sistema de cría y puesta.
Densidad animal – una decisión importante
La densidad de alojamiento es un parámetro que debe definirse antes de la recepción de animales ya que tiene un impacto directo tanto en la cría como en la puesta del desarrollo corporal, la uniformidad del lote y la ingesta diaria.
Las gallinas, como cualquier otro animal de sangre caliente, tienen herramientas biológicas para regular su temperatura corporal.
Sin embargo, esta capacidad es limitada y los períodos prolongados de altas temperaturas pueden afectar directamente el comportamiento del ave. La disminución en el consumo de alimento, el deterioro de los factores productivos, así como mayor estrés de los animales suelen observarse cuando esto ocurre.

El programa de luz en gallinas ponedoras es una herramienta esencial para orientar a las aves hacia un tipo de producción concreto. Esto es especialmente cierto para el tamaño de huevo ya que tanto el programa de luz en recría como el momento de estimulación lumínica tienen un efecto mayor sobre este parámetro.
Durante la fase de puesta el tiempo de luz nocturna puede variar entre 60 y 120 minutos, pero en cualquier caso debe estar precedido y seguido por un periodo de oscuridad de, al menos, 3 horas como se muestra en el siguiente gráfico.
Luz
Oscuridad Alimentación 3 3 16 2
Figura 2. Programa de luz en un periodo de 24 horas.
Los programas de luz en recría van a afectar el crecimiento del ave ya que disponen el tiempo que tiene el ave para alimentarse. Tal y como se ha descrito anteriormente, esto tiene un efecto claro y directo sobre la capacidad de esta para producir masa de huevo y por consiguiente afectara al tamaño de huevo.
Desde un punto de vista conceptual, la actividad de puesta de la gallina se podría reducir a transformar kilos de alimento en kilos de masa de huevo. Esa masa de huevo es el producto del número de huevos puesto por el peso de estos y depende principalmente de la genética del ave, así como de su correcta alimentación y manejo.
Masa de huevo = Nº de huevos X peso medio del huevo
Nº de huevos
Es importante reseñar que en gallinas ponedoras comerciales no existe periodo foto refractario como sí ocurre en otras especies de aves. Esto implica que las aves son sensibles a la estimulación lumínica desde edades tempranas.
Por ello se debe ser cuidadoso en no estimular a las aves durante la recría para evitar un adelanto en la entrada a producción no deseada.
Entre los indicadores más interesantes para este propósito están los siguientes:
Peso al inicio del estímulo lumínico
Es el mejor indicador operacional para saber cuándo estimular el lote de manera precisa. Sin embargo, requiere hacer pesajes del lote semanalmente e incluso más frecuentes en las semanas previa a la estimulación. Igualmente es un dato que funciona muy bien en lotes con pesos homogéneos, pero no es tan preciso en lotes desuniformes.
Tamaño de huevos
El programa de luz juega un papel determinante
Edad al inicio del estímulo lumínico
Es el indicador operacional más usado para decidir cuándo iniciar la estimulación del lote. Correlaciona bien con peso al inicio del estímulo lumínico si el lote tiene un peso corporal cercano al estándar y es uniforme.
Las gallinas ponedoras empezarán a poner cuando alcancen un peso adulto, si el fotoperiodo no es inhibidor o han perdido el ciclo circadiano.
Los fotoperiodos los podemos clasificar en:
Estimulantes
Son aquellos con un fotoperiodo creciente, es decir en los que los días aumentan en duración. Las gallinas expuestas a esta iluminación tienden a adelantar este inicio de producción.

Decrecientes o constantes
No son estimulantes y no promueven la entrada a puesta.
Es un buen indicador predictivo de cómo será la producción del lote y de cómo ha funcionado el programa de estimulación. Es muy difícil obtener el peso exactamente en sistemas de jaula ya que requiere hacer un peso de la nave tras la recogida de los huevos, pero en sistemas alternativos con los nuevos sistemas basculas en granja puede ser más fácil.
Edad al 50% de puesta
Es un dato predictivo de la producción del lote fiable siempre que el lote esté en el peso estándar y y sea uniforme. Es mucho más usado que el peso al 50% de puesta pues es muy fácil de calcular si el productor recoge los huevos del lote diariamente o cada dos días.
El tamaño del huevo puede controlarse con la nutrición de las aves, pero esta no funcionara si antes no se han realizado correctamente las otras prácticas recomendadas en este documento.

Las necesidades energéticas se dividen en tres partes en la producción en jaula:
Las necesidades de mantenimiento suponen un 65% del total de las necesidades en producción y salvo al principio de la producción donde hay un crecimiento del ave es significativo. En el resto de la producción, el resto de la energía se destinará a la producción de masa de huevo.
La gallina necesita sus necesidades de mantenimiento cubiertas antes de destinar recursos a la producción del tamaño de huevo.
Los conceptos nutricionales que condicionan el tamaño del huevo son 4, pero en las gallinas fuera de jaula el impacto de la energía será mayor por el sistema de producción en el que van a estar alojadas.
En la producción de gallinas libre de jaula hay dos nuevos gastos energéticos que hay que tener en cuenta, las gallinas van a tener un aumento de la actividad física y además van a estar expuestas a unas condiciones climáticas no tan controladas como cuando están en la nave cerrada y en jaula.
La temperatura tiene un efecto en la capacidad de consumo, pero también en las necesidades de mantenimiento.
Temperaturas por debajo de 20⁰C estimulan en consumo y aumentan las necesidades calóricas del ave y temperaturas por encima de los 20⁰C reducen el consumo de las aves y además aumentan las necesidades calóricas del ave (Ver Figura 3).
Necesidades de energía según temperatura
15 16 17 18 19 20 21 22 23 24 25 26 27 28 29 30
Temperatura (ºC)
El ave en sistemas alternativos o en situaciones de estrés calórico va a priorizar el uso de la energía ingerida para el mantenimiento y eso reducirá la disponibilidad para la producción.
Hay que recordar que la energía del alimento viene de 4 elementos y la gallina no va a hacer distinción cuando las necesidades de mantenimiento son una prioridad.
La energía en el alimento son: almidón, proteína, grasa y azucares.
Las gallinas pueden utilizar cualquiera de estos componentes como fuente de energía.
En producciones de huevo libre de jaula hay que contemplar un aumento de las necesidades energéticas, para que la gallina no empiece a metabolizar aminoácidos que son clave para obtener un tamaño de huevo que deseamos.
Gallina con actividad y afectada por temperatura
Aumentan las necesidades de energía
Los aminoácidos se metabolizan
Faltan aminoácidos clave en formación del huevo
Huevo pequeño
Los aminoácidos son las piezas fundamentales para hacer crecer el tamaño del huevo alrededor de la yema. La proporción de los aminoácidos necesarios en el huevo no varían, lo que varía es la cantidad necesaria para “construir” un huevo más grande.
Luego sigue una serie de aminoácidos que también limitaran el tamaño de huevo como son Treonina, Triptófano, Isoleucina, Valina y Arginina.
Por ello en la dieta hay que estar seguro de que tenemos los 7 aminoácidos principales bajo control y además que el resto de los aminoácidos quedan cubiertos con un mínimo de proteína.
Huevo pequeño
Importancia del tamaño del huevo DESCÁRGALO EN PDF
Huevo grande

Joan Monllao Director de Operaciones de Ous Roig Tortosa, SAU; Hevo Group

Hablar de costes de producción, en el sector avícola de puesta, como en cualquier otro, es parecido a la búsqueda del “santo Grial”. Todo el mundo habla de ello, pero no existe un “cáliz sagrado”, (concreto y universal), que proporcione la eterna “juventud” (solución o equilibrio).


De todas maneras, si estaremos de acuerdo en que hay varias premisas claras:

Dado que el precio de venta está muy controlado por la Gran Distribución, actualmente no nos queda otro remedio que trabajar “hacia dentro”, es decir, “optimizar ” nuestros costes.
Acción que debería ir acompañada, de una vez por todas, por el compromiso del sector en alinearse y hacer frente común.
Conocemos que entre un tipo de cría y otro existe un diferencial de coste, difícil de estandarizar, ya que depende de: tipo de alojamiento, tipo de alimentación, fases propias o externalizadas, tipo de cliente, antigüedad de la granja, etc,…
pero aún así sabemos que la producción alternativa está muy sujeta al comportamiento “explorador” de las aves y en consecuencia a su mayor necesidad de asegurar la alimentación (cuando, como y con qué), el ambiente, la ventilación, la gestión de la gallinaza, etc …
Según algunos estudios, la producción de huevos en sistemas de suelo puede suponer un 17% más de coste y el sistema campero puede alcanzar un 30% de diferencial sobre el de jaula.
17%$ + de coste
SISTEMA GALLINAS SUELO
30%+ de coste
SISTEMA CAMPERO JAULA ENRIQUECIDA
Existen unos costes “estandarizados”, que son bien conocidos por todos los avicultores. Estos los podemos dividir en:
Conversión: Alimentación y medicamentos en la fase de puesta sobre docena producida.
Costes directos: Personal, servicios externos tales como: técnicos, mantenimiento, limpieza y desinfección, suministros, amortización instalaciones, etc …

Costes indirectos: Impuestos, seguros, reparaciones generales, etc.
Amortización aves puesta: el coste de recría y hasta llegar al arranque de puesta, deben amortizarse, en función de su producción, como si de una máquina se tratase.
Dejaremos para otra ocasión los costes de clasificación, expedición y comercialización, que tienen lugar en las fases posteriores a la producción. 1 2 3



¡Ahorre en promedio 6 gramos de pienso por gallina al día! La calidad
del aire influye en el rendimiento de sus aves
El ECO Unit es un intercambiador de calor que mantiene un clima saludable con una ventilación mínima. Esto ayuda a optimizar el consumo de alimento e incluso a aumentar la producción de huevos por gallina y lote.
Ahorre costes, mejore el bienestar animal de sus gallinas y optimice el rendimiento de su empresa con el ECO Unit.
Calcula tu amortización ¡en solo 2 minutos!
Cálculo meramente orientativo. Para un cálculo más preciso del ahorro, póngase en contacto con nuestros expertos en clima.

Escanea el código QR
Calculadora de ahorro de pienso
Contacta con nosotros

Agustin Martin Ramos
Area Sales Manager
698 437 354 agustin.martin@vencomatic.es
Vencomatic Ibérica S.L. 977 331 908 info@vencomatic.es C/ Pintor Fuster, 21 43205 REUS (Tarragona)
Sobre todos estos puntos existe mucha información disponible y son de sobra conocidos y tratados por los diferentes compañeros del sector.
Hoy en día existen herramientas de consulta e información, con las que podemos comparar nuestros costes económicos con los de otros productores del sector, de forma anónima.
Un ejemplo es la presentación que se realizó en el último Aviforum Puesta aviNews de de San Sebastián 2023, por parte de la empresa SIP, SL (Sistemes d’Informació per la Producció, SL), así como otros muchos basados tanto en estudios económicos como en la bioestadística.
Aparte de todas esas premisas que conocemos, podemos dividir los costes en intangibles y en organizativos.

A mi parecer, estamos ante un antes y un después en nuestro sector, principalmente debido a:
Nuevos sistemas de cría de animales con gran influencia de su comportamiento.
Cambios en las tendencias de compra de los consumidores.
El sector se halla ante un relevo generacional, prácticamente inexistente.
Estos “inputs” se dan a la vez y dibujan un panorama en la avicultura de puesta, donde estamos pasando de un sistema de producción vertical (integración), a un sistema de producción horizontal, en el que ganan protagonismo los grandes grupos de productores, con una configuración de explotaciones en propiedad,
lo que confiere una mayor profesionalización y un elevado protagonismo a los equipos de trabajo propios o externalizados.
La organización es clave y por ello el liderazgo, pilotaje, composición y funcionamiento son el nuevo motor, que reemplaza el modelo anterior de un solo líder “omnipresente “, normalmente la propiedad.
Aquellos asociados a la gestión NO económica, y que hacen que ya no tan solo debamos tener una Dirección técnica enfocada a los buenos resultados productivos de las aves, sino también, sobre todos los diferentes actores del proceso, principalmente:
Los nuevos sistemas llamados “alternativos”, confieren una mayor participación del personal en las explotaciones.
Requieren de una mayor capacitación (invertir en formación) y de su integración, hacer sentir, que forman parte del equipo, que son un engranaje esencial junto con las aves, para la obtención de buenos resultados. Sus decisiones y acciones tienen repercusión en la alimentación, recría de las aves, ambiente, bioseguridad, manejo, …
Hay que tener en cuenta que, en los sistemas de cría mencionados, nuestros granjeros suponen el segundo o tercer coste en importancia después de la alimentación de las aves y de su recría.
Por ello, si nos preocupamos tanto por una alimentación y unas pollitas eficientes y de calidad, ¿Por qué no también del personal?

Precisamos granjeros profesionales, ya que principalmente deben tener intuición, capacidad de análisis y de toma de decisiones.
Hemos pasado a tener unos sistemas de producción alternativos dónde hay que poner en valor este actor, al mismo nivel que los costes citados, en los que invertimos tiempo y capital.
A nuestros encargados debemos capacitarlos gestión de personal, ya que se ha vuelto necesario el saber gestionar equipos.
Un manejo de grupos de trabajo, junto con adecuadas condiciones en su labor diaria (ropa, vestuarios, comedor, horarios …), está demostrado que mejora la productividad.
Tenemos que proporcionar información continuada: qué queremos y qué obtenemos.
Compartir los resultados sobre un objetivo es vital, no sólo lo que no se hace bien.
Que dispongan y conozcan el plan de trabajo para intentar alcanzar los objetivos de un lote de gallinas, sobre todo durante los primeros meses de puesta.
GREEN WAY 30 MAX para PONEDORAS

GREEN WAY 30 para PONEDORAS
GREEN START para CRÍA-RECRÍA
VISION para PONEDORAS
VISION ASIMÉTRICO para PONEDORAS
VISION SURFACE para PONEDORAS
GREEN WAY 24 MAX para PONEDORAS
VISION LARGE SURFACE para PONEDORAS
GREEN WAY 24 para PONEDORAS
Realizar reuniones con todo el equipo de la granja, al menos tres o cuatro veces al año, compartiendo y tratando los resultados obtenidos y debatiendo sobre la aplicación de los planes de trabajo.
Es primordial que conozcan los riesgos sanitarios que conlleva su trabajo con respecto de las aves y la continuidad del negocio y no como una imposición de la empresa.
Hacerles comprender que cualquier variación por pequeña que sea, debe ser revisada. Lo que apuntan en los registros, no son solo datos. Inculcar el análisis o pre-alarma de la variación de los datos.

Por ello, a menos aves = menos huevos, nos obliga a analizar otros parámetros no productivos de las aves, como, por ejemplo:
Existe una obligación en estudiar de forma detallada cada parte del proceso, analizando en cada etapa los diferentes inputs internos y externos que nos afectan, así como la forma en que se desarrolla cada actividad de la etapa.
Hay que volver a plantearnos el cómo y el porqué de cada acción y no dar nada por aceptable. Ya no sirve el por qué “siempre se ha hecho así”. Recordemos que el sistema de producción ya no es como “antes”.
De inicio, ya partimos en que las densidades de aves en los nuevos sistemas de producción ya no son como las de jaula, tanto por el propio sistema alternativo, como por qué ha quedado demostrado que menos, es más, una menor densidad en sistemas alternativos ayuda a tener unos resultados productivos más eficientes.
Consumos de energía: requerimos de mayor ventilación, más repartos de pienso, recogida de huevo con mayor periodicidad, etc, …
Mantenimiento preventivo: reparaciones reiteradas, averías que paralizan los procesos de recogida, alimentación en forma y tiempo adecuados, etc …
Automatizaciones: estudio de la incorporación de I+D+i para ser más eficientes, sin perder la parte humana que con su “sensibilidad y cuidado” de las aves, ayuda a adaptar manejos y evitar que situaciones críticas empeoren.
Huevo no vendible: estudiar el proceso para detectar puntos críticos, que no son causa directa de las aves y que perjudican la calidad de huevo, para aplicar las actuaciones pertinentes.

En este estudio de la eficiencia del proceso, es muy importante disponer de toda la información para poder realizar una toma de decisiones adecuada NECESITAMOS:
Inputs que afectan a la puesta (con mayor periodicidad de recogida y gestión)
Análisis de coste (explotación y nave)
Obtenemos
DETALLE DE LOS COSTES EN TODO EL PROCESO
Permite
ACTUAR SOBRE EL COSTE CONCRETO
Podemos aprovechar aquí las nuevas tecnologías digitales que facilitan la labor de recogida y tratamiento.
Los consumidores…
Los consumidores se están replanteando sus valores éticos, dando mayor protagonismo a aquellos que relaciona con el medio ambiente y la sociedad que nos rodea:
Contaminación y recursos naturales
Bienestar animal
Igualdad y derechos de las personas
Conciliación laboral
Creación de empleo
Conocer el origen y el proceso de los alimentos que consumen
Todos estos aspectos conllevan una gestión interna y externa que también supone unos costes.
Adaptar instalaciones
Implantar planes de gestión, sistemas de trazabilidad y control
Personal dedicado a su gestión
Cambios en la gestión de los recursos

Informes de sostenibilidad públicos
Declaraciones a la administración
Empresas de certificación
Presencia en redes sociales de forma activa
“Publicitar” nuestro impacto en la sociedad y sobre las empresas que nos rodean
Existen diversos sistemas de medición del impacto, seguimiento y gestión de estos costes. Los más conocidos son los KPI’s (Key Production Indicator) o ratios de productividad, que no necesariamente deben estar correlacionados de forma directa con un coste productivo como tal.

Nos ayudarán tanto a ver la situación de partida, como la evolución que siguen, así como en la toma de decisiones y actuaciones para la mejora de estos de cara a la optimización y eficiencia de los costes. Cada empresa debe desarrollar sus KPI’s en función de sus objetivos.
Algunos ejemplos, más allá de los meramente productivos de nuestras aves:
kW de consumo por docena producida
Coste servicios externos por docena producida o por m2 de nave
Coste de limpieza y desinfección por m2 de nave o de superficie de gallina
Coste reparaciones por huevo producido
Huevo vendible por operario de granja
Nº de incidencias avería por docena
Tiempo efectivo de trabajo en granja por docena recogida o docena vendible
Coste de vacunas y medicamentos sobre gallinas muertas o vivas
Debemos ir más allá de los costes habituales para detectar y analizar todo lo que nos influye en nuestro proceso y organización.
Tenemos que abordarlo, no como una reducción de estos, sino como la búsqueda de la optimización de estos y que culminará posiblemente en una reducción de coste u otras actuaciones.
No hemos abordado aquí el funcionamiento interno de nuestras organizaciones, como eje clave para el desarrollo de los puntos anteriores, ya que su extensión y detalle da para otras “temporadas” o “secuelas”.
Estamos en un gran momento para dar un paso más en la profesionalización de nuestro sector, a nivel zootécnico, de calidad y seguridad alimentaria, ya lo hemos alcanzado.
Hay que ponerlo en valor como un modelo de negocio empresarial rentable, ya no somos granjeros, ya no somos productores de huevos... somos empresarios que disponemos de un producto esencial y de gran calidad alimentaria.

GSrandes cambios se han producido en el mundo de la incubación industrial desde la llegada de la monoetapa, máquinas controladas por termostatos y con paneles analógicos han dado paso a modernas máquinas equipadas con medidores de temperatura de embriones, controladores de CO₂, lecturas computarizadas y otras tecnologías.

e han introducido restricciones en las prácticas de tratamiento del pico en algunos países y además están siendo consideradas por muchos otros. Los picos completos (no tratados) son obligatorios en lotes de aves de producción de huevo ecológico en la Unión Europea, y esta práctica se está extendiendo voluntariamente a más aves. El manejo de los lotes de aves que tienen el pico completo requiere más consideración y cuidados en relación con los lotes de aves con el pico tratado.


Existen factores clave a considerar en el manejo de lotes con el pico completo:
Calidad de la pollita
Iluminación
Ventilación
Medio ambiente

Mientras el manejo es un componente importante para el éxito de los lotes con el pico completo, la genética también juega un papel importante.
Manejo del sistema de alimentación
Nutrición y especificación de nutrientes en la dieta
El objetivo de la crianza de los lotes de aves con el pico completo es trasladar las aves con una excelente cobertura de plumaje, buenos atributos de comportamiento, buen peso corporal y uniformidad de alto peso corporal con una buena condición corporal en general.
Cuanto mejor sea la condición general del lote de aves al momento del traslado, mejor será su comportamiento y condición de plumaje durante todo el período de puesta.
Las variedades han sido creadas para ser particularmente tranquilas, sociables y tienden a no expresar un comportamiento agresivo durante los eventos de estrés.
La crianza puede tener un impacto significativo en el comportamiento de las aves más adelante en la vida.
Las aves sociables durante la crianza tienden a mantenerse sociables en el período de puesta, mientras que los lotes de aves que exhiben un comportamiento antisocial durante la crianza tienden a mantener ese mismo comportamiento en la postura.


Factores que contribuyen a un buen comportamiento del lote:
Uniformidad
La buena uniformidad corresponderá con una mejor integridad y comportamiento del lote.

La cobertura de plumas
Un ave con pocas plumas al inicio de la puesta es más propensa al estrés durante este período.
Los factores que contribuyen a la calidad de las plumas incluyen el crecimiento adecuado, la nutrición, las enfermedades, el manejo, el estrés general y la uniformidad.
Las pollitas padecen tres mudas para pasar de la cobertura de plumas de pollitas hasta la cobertura de plumas de aves adultas.
Para lograr el mejor plumaje, las pollitas deben estar sanas y libres de estrés durante el crecimiento de las plumas.
Acondicionamiento ambiental
Las aves que son menos excitables debido a estímulos externos están menos estresadas y serán más sociables.
Cama
Proporcionar una cantidad de cama adecuada todo el tiempo.
Una cantidad de cama inadecuada durante la crianza puede resultar en un comportamiento de picoteo de plumas más tarde en la postura.
Estímulos auditivos y visuales
Acondicionar a las pollitas durante la crianza con estímulos auditivos y visuales.

Los ruidos mecánicos, como cuando se inicia el sistema de comederos, son una buena forma de acondicionar a las aves al ruido espontáneo.
El uso de una radio en la nave de crianza familiariza a las aves con sonidos.
Los granjeros deben caminar por la nave y entre las aves para que se acostumbren al contacto humano.
El cambio frecuente del color de la ropa y del calzado también ayudará a que las aves tengan un estímulo visual.

Durante la crianza adaptar las aves al equipo y mobiliario de la nave de postura.
Proporcionar perchas/slats adecuados en la nave de recría y utilizar el mismo sistema de alimentación que se utiliza en la puesta.
Los comederos de cadena a menudo son utilizados en los sistemas en aviarios y al aire libre, ya que están asociados con una menor selección de alimento y desperdicio, por lo que la introducción a este sistema en la nave de crianza ayuda a que las aves se familiaricen al sistema.
Enriquecer el medio ambiente con perchas, plataformas elevadas con agua y alimento, forraje, bloques para picotear y baños de polvo.
Estos enriquecimientos pueden evitar el picoteo de las plumas y deben introducirse a una edad temprana.

Colocar la cantidad de aves en las proporciones recomendadas para proveer suficiente lugar en los comederos, bebederos y suficiente espacio en el piso para minimizar el estrés social.
Peso corporal y uniformidad
Se debe lograr un peso corporal, acondicionamiento y uniformidad óptimos al final del período de crianza.
Lo ideal es que el peso corporal sea de 100 –150 g por encima de las recomendaciones a las 18 semanas de edad con una uniformidad del 85%.




El programa de iluminación de las pollitas es esencial para apoyar en general el peso corporal y el crecimiento de las plumas durante la crianza. Hay tres componentes principales en cualquier programa de iluminación:
la disminución inicial, el período constante.
la estimulación.
Se debe utilizar un programa de iluminación intermitente para las pollitas entre las 0 y las 2 semanas de edad.
Este programa proporciona (Figura 2) ciclos de períodos claros y oscuros, que proporcionan a las pollitas períodos de descanso durante cada período de 24 horas.
El comportamiento de descanso y la actividad del lote están sincronizados. Como las pollitas no han desarrollado aún un ritmo circadiano (24 horas), el programa intermitente puede modificarse para adaptarse al horario de trabajo de la granja.
La recomendación es proporcionar entre 3 y 6 períodos de oscuridad, que varían de 1 a 2 horas cada uno, los cuales se pueden adaptar en los lotes que tienen exposición a la luz natural durante el día.
2 horas
4 horas
2 horas
4 horas
4 horas
2 horas
4 horas
2 horas
Figura 2 . Programa de iluminación intermitente para pollitas.
La intensidad de la luz de 0 a 3 días de edad debe ser de 40 a 50 lux, reducida a 25 lux al final del programa de iluminación intermitente.
Disminuir la intensidad de la luz a 10–15 lux a más tardar a las 4 semanas de edad y continuar hasta 2 semanas antes de la estimulación.
Las luces deben ser LED y que no parpadeen para minimizar el estrés:
3000–5000 Kelvins en crianza
2700–3000 Kelvins en postura
Después de terminar con la iluminación intermitente, proporcionar 18 horas de luz constante con 6 horas de oscuridad y comience con la parte de disminución de luz del programa de iluminación.
Utilice un programa decreciente lento hasta alcanzar de 10–12 horas a las 12 semanas de edad.
La duración constante del día empezando de 10 a 12 semanas hasta la estimulación.
La duración constante del día se basa en la historia de la granja, la estación y el tiempo de luz natural presente a las 16 semanas de edad.
Un día más largo constante permitirá más oportunidades de alimentación y mejorará el crecimiento si es necesario para climas cálidos o condiciones difíciles.
La meta del peso corporal para los lotes con el pico completo es al menos 5% superior al estándar. Si las aves no están 5% arriba de la meta a las 8 semanas de edad, ajustar el programa de iluminación para permitir una mayor duración del día.
Para limitar estrés durante el traslado, los programas de iluminación deben coincidir (duración e intensidad) y el tipo de iluminación (por ejemplo, LED) tanto en las naves de crianza como en las de puesta.
Mantener la misma intensidad de luz durante los primeros 3-4 días después del traslado para permitir que las aves se adapten a su medio ambiente.
Asegúrese de que el período de la duración constante del día sea por lo menos de 3 semanas después de que se complete la disminución.
Después de este período, instaurar el programa de iluminación de puesta. La exposición a un poco de luz natural en la nave de crianza puede ayudar a que las aves se acostumbren a la luz natural si está estipulado en la nave de postura (Figura 3).



Luz natural del día en naves de crianza y puesta.
Estimular las aves alcanzando la meta del peso corporal. El retrasar la estimulación puede ayudar a aumentar el promedio del peso del huevo. Utilizar una estimulación inicial de 1 a 2 horas siendo la meta alcanzar de 15 a 16 horas de luz total a las 24 semanas de edad.
Adaptar la intensidad de la luz al comportamiento de las aves, aunque la intensidad de la luz interior puede ser controlada por la legislación local.
Las recomendaciones son 20–30 lux al nivel de los comederos o de la cama en los aviarios. Las aves pueden estar expuestas a niveles mucho mayores con ventanas, cortinas o con acceso al aire libre.
Una menor intensidad de luz dentro de la nave ayudará a calmar a las aves si es necesario.
Asegurar que la luz directa no brille en el área de los nidos y que sea seguro para que las aves pongan sus huevos sin la intrusión de otras aves.
Cuando las aves están en el nido, puede ocurrir un picoteo perjudicial de la cloaca cuando sobresale temporalmente después de poner un huevo.
Un medio ambiente con mala ventilación puede aumentar el estrés y conducir a un comportamiento de picoteo de plumas.
Cuando los niveles de amoniaco en la nave de puesta excedan de 15 ppm, aumenta la incidencia del picoteo de plumasal 10%.
De la misma manera, cuando los niveles de CO₂ aumentan a 100 ppm, la incidencia del picoteo de plumas aumenta al 15%.
El sistema de ventilación debe ser eficiente para remover del ambiente el CO₂, el amoniaco, la humedad, el polvo y el exceso de calor.
Como cada nave se ventila de manera diferente, se recomienda consultar con un especialista para asegurarse de que el sistema de ventilación esté operando de manera óptima.


Los sistemas de ventilación con presión de aire negativa funcionan de manera que el aire se extrae de las entradas laterales al techo, por donde el aire que entra se mezcla con el aire caliente y luego circula por la nave.
Esto proporciona una temperatura del aire homogénea y evita que el aire frío baje de las entradas de aire directamente sobre el área de la cama, creando áreas húmedas.
Calentar la nave antes de la llegada de las aves de la granja de crianza; la nave de puesta debe estar caliente a la llegada de las aves.
Asegurar que el medio ambiente de la nave de postura sea óptimo: de 18–25°C y con una humedad de 40–60%.
Evitar que los gases excedan a los niveles máximos permitidos.
Las naves con presión positiva empujan el aire de escape a través de las rejillas de ventilación y de los orificios, evitando que el aire frío y húmedo durante el invierno ingrese a la nave causando humedad en la cama.
Los sistemas de ventilación natural (Figura 4) se basan en la flotabilidad térmica. Las aves generan aire caliente, que se eleva.
A medida que sale el aire caliente, el aire fresco del exterior del edificio ingresa a la nave por las entradas laterales.
La ventilación natural está influenciada por las condiciones climáticas externas y es más difícil de manejar que los sistemas de ventilación mecánica.
La ventilación natural generalmente no se recomienda cuando las temperaturas exteriores superan los 33° C.
Proporcionar suficiente circulación de aire utilizando ventiladores suplementarios durante el clima cálido para ayudar a refrescar a las aves.
El manejo de los lotes de aves que tienen el pico completo. Parte I DESCÁRGALO EN PDF

4 . Una ventilación natural en la nave con ventiladores.






En Instalaciones Agropecuarias
Cosma, líder en la fabricación de cobertizos, estamos orgullosos de presentar nuestra línea de cobertizos multifuncionales, diseñados para satisfacer las necesidades únicas de cada cliente.
Estos cobertizos no solo ofrecen versatilidad y funcionalidad, sino que también se adaptan perfectamente a cualquier requerimiento específico gracias a la flexibilidad en sus medidas y materiales de construcción.



Ofrecemos cobertizos en medidas estándar de 6 m, 8 m, 10 m y 11 m de anchura. Sin embargo, al ser fabricantes directos, tenemos la capacidad de adaptarnos a medidas más específicas según las necesidades particulares de cada cliente.
Esta adaptabilidad nos permite proporcionar soluciones personalizadas que encajan perfectamente en cualquier espacio, asegurando la máxima eficiencia y utilidad.
La cubierta de nuestros cobertizos puede ser confeccionada en diversos materiales de alta calidad:
Lona de PVC específica, ideal para aplicaciones generales.
Lona de PVC opaca con propiedades aislantes, perfecta para necesidades de aislamiento térmico.
Chapa grecada pre-curvada desde fábrica, que ofrece robustez y durabilidad, con posibilidad de colocar lucernarios para la entrada de luz natural.
Para clientes que requieran aislamiento adicional, podemos instalar una o dos capas de aislante de fibra de vidrio debajo de la cubierta, garantizando así un entorno controlado y protegido.
6 m, 8 m, 10 m y 11 m



Los frontales de nuestros cobertizos pueden diseñarse abiertos o cerrados, y se pueden incluir puertas de acceso si es necesario.
Esta flexibilidad en el diseño asegura que cada cobertizo cumple con las especificaciones exactas del cliente, proporcionando accesibilidad y funcionalidad óptimas.
Ya sea que necesite un acceso fácil para vehículos o un almacenamiento seguro y cerrado, podemos personalizar el diseño para adaptarlo a sus necesidades.


Una de las grandes ventajas de nuestros cobertizos es que generalmente no requieren de un proyecto visado necesitando solo una licencia de obra para su construcción.
Además, estos cobertizos pueden ser colocados directamente en el suelo, sobre una solera, sobre muros de hormigón o sobre muros prefabricados de hormigón, sin necesidad de cimentación, lo que facilita y agiliza su instalación.
COSMA, siempre a la vanguardia de las últimas tecnologías, equipa las naves avícolas y otras instalaciones de almacenamiento con todos los elementos necesarios para la más eficiente explotación.
Nuestros cobertizos están diseñados para maximizar la eficiencia y la rentabilidad, proporcionando soluciones de almacenamiento perfectas.


Bajos costos de realización:
Ofrecemos soluciones rentables sin comprometer la calidad.
Amplia oferta: Nos adaptamos a sus necesidades específicas, ofreciendo una variedad de características personalizables.
Construcciones de gran calidad: Nuestros cobertizos están construidos para la durabilidad y tienen una larga vida útil.
Confianza y experiencia: Con más de 30 años de experiencia, COSMA ha ganado la confianza de sus clientes a través de un servicio constante y confiable.

Medidas estándar de10m. 12,5m. 14m.de ancho 10m 12,5m 14m
Ventilación y aislamiento excepcional Proyectos llave en mano
Las más de 550 naves de experiencia nos avalan
Después de más de 30 años dedicados a la producción de cobertizos y otras estructuras agrícolas, COSMA agradece sinceramente a sus clientes por su confianza y apoyo a lo largo de nuestra historia. Nos comprometemos a seguir proporcionando soluciones de primera calidad que satisfagan las necesidades en evolución de nuestros clientes.

Cobertizos
Ganaderos
Cosma
almacenamiento, refugio, ganado, etc.


Polg. Ampliación Comarca I
Soluciones a medida con Cosma y sus cobertizos multifuncionales
DESCÁRGALO EN PDF
Sin necesidad de proyecto
Calle M, nº6 - 31160 ORCOYEN (Navarra) Tel 948 317 477 Fax 948 318 078 cosma@cosma.es www.cosma.es
Nestor Ledesma Martínez
Departamento de Medicina y Zootecnia de Aves
Facultad de Medicina veterinaria y Zootecnia
Universidad Nacional Autónoma de México

Las líneas modernas de aves se caracterizan por su alto rendimiento y especialización. Los avances en materia de genética, alimentación, manejo, medio ambiente y reproducción han mejorado los parámetros productivos de manera significativa.



Si bien las aves de hoy en día son más eficientes y productivas, también son menos rústicas que en el pasado por lo que son más susceptibles de enfermedades.

Por este incremento en la susceptibilidad, las producciones modernas requieren medidas estrictas de bioseguridad y calendarios de vacunación eficientes.
En la actualidad se cuenta con más y mejores vacunas, sin embargo, se requiere que el sistema inmune de las aves se encuentre en condiciones óptimas de funcionamiento.
Agentes físicos como los cambios bruscos de temperatura, manejo durante las vacunaciones, selección, reagrupamiento.
El sistema inmune se ve sometido constantemente a agentes inmunodepresores de diversos tipos;

Debido a la etiología multifactorial para la inmunodepresión, el diagnóstico no siempre es sencillo, pues se requiere de una historia clínica, necropsias y en su caso pruebas de laboratorio complementarias.
Es muy importante para el clínico de campo el conocimiento de los cambios macroscópicos que durante la necropsia se pueden observar en el sistema inmune. Esto orienta el diagnóstico y facilita la toma de muestras.
A continuación, se discuten los aspectos más relevantes de la patología del sistema inmune orientada a inmunodepresión.
Agentes químicos como micotoxinas y aminas biogénicas.
Agentes biológicos como los virus.
Glándula de Harder
Hígado
Tonsilas cecales Bazo Timo
El sistema inmune de las aves está conformado por órganos linfoides primarios y secundarios.
Durante la etapa embrionaria, a partir del saco vitelino migran células indiferenciadas a la médula ósea, al timo y a la bolsa de Fabricio.
En estos órganos las células se diferencian a linfocitos T o B en donde expresan marcadores de superficie y mediante selección negativa se eliminan aquellos linfocitos que no son útiles.
Posteriormente migran a los órganos linfoides secundarios tales como el bazo, tonsilas cecales, glándula de Harder, tejido linfoide asociado a mucosas, y centros germinales en tejido conectivo.
La interpretación de lesiones en órganos linfoides requiere tomar en cuenta la edad de las aves y calendario de vacunación, ya que los órganos linfoides primarios sufren atrofia cuando las aves alcanzan la madurez sexual y la mayoría de las vacunas que se aplican de rutina ocasionan cambios en los órganos linfoides.

Esta se presenta únicamente en las aves, se ubica en la parte dorsal de la cloaca, conectada al intestino mediante un conducto.
La bolsa de Fabricio es el sitio de diferenciación de los linfocitos B y capta antígenos al momento que el ave defeca, ya que la capa de músculo liso del intestino continúa en la bolsa de Fabricio de modo que la contracción del músculo hace funcionar a la bolsa como una perilla de succión.
En el interior de la bolsa de Fabricio se aprecian folias mayores y menores, estas folias están recubiertas por un epitelio cilíndrico y contienen los folículos linfoides sostenidos por una matriz de tejido conectivo.
Cada folículo linfoide está conformado por una corteza y médula, separadas por una capa de células cortico-medulares que se continúan con las células del epitelio que reviste las folias.




La bolsa de Fabricio, en ausencia de agentes infecciosos o inmunodepresores, debe estar presente hasta las 12 o 14 semanas de vida del ave, tiempo en el cual inicia su involución, de modo que a las 20 semanas únicamente quedan vestigios.
En las aves de producción, el uso de vacunas, principalmente contra la infección de la bolsa de Fabricio, ocasiona atrofia antes de este tiempo.
La bolsa de Fabricio con involución se aprecia macroscópicamente como un nódulo pequeño, duro y de color blanco amarillento.
Al microscopio, las folias son pequeñas, los folículos han perdido la diferenciación entre corteza y médula, el epitelio presenta pliegues y quistes.
El timo en las aves se ubica a lo largo del cuello, está compuesto de 6 a 7 lóbulos que van paralelos a las venas yugulares y el nervio vago.
En el timo se diferencian los linfocitos T.
Macroscópicamente los lóbulos del timo se aprecian con pequeños lobulillos y al corte se diferencia una corteza y médula.
En ausencia de agentes infecciosos o inmunodepresores, el timo debe permanecer hasta las 15 o 17 semanas, después de ese tiempo inicia su involución de modo que a las 30 semanas quedan únicamente vestigios.
El examen histológico de timos con involución muestra pérdida de la corteza y fibrosis de médula.

En los pollitos de 1 día, es frecuente encontrar conglomerados de heterófilos en el tejido subepitelial, estos son focos de granulopoyesis extramedular y son comunes en varios tejidos del pollo.
Sólo los huesos no neumáticos como el fémur y tibiotarso presentan médula ósea, se le considera órgano linfoide primario y secundario ya que de la médula surgen:
Células indiferenciadas que migran al timo y bolsa de Fabricio en la vida embrionaria y;
Por otra parte, son fuente de estas mismas células en los animales adultos o bien en la repoblación de timo y bolsa posterior a daños severo con pérdida de linfocitos.


El bazo se encuentra unido a la molleja y proventrículo por su cara visceral, es órgano linfoide secundario, está conformado por una cápsula de tejido conjuntivo y trabéculas sobre las cuales se sostienen:
Los centros germinales (pulpa blanca) y arteriolas.
Las células dendríticas.
Los glóbulos rojos (pulpa roja).
El bazo en los pollitos jóvenes es un centro de granulopoyesis y en las aves mayores un centro de presentación de antígenos.

El proceso de apoptosis es normal en las aves durante los procesos de selección negativa de las clonas que no son de utilidad. En un corte histológico de órganos linfoides se aprecia apoptosis que se describe en los textos como “cielo estrellado”.
Este aspecto se considera fisiológico a menos que la apoptosis sea tal que disminuya el tamaño del órgano.
Por otra parte, las micotoxinas son consideradas como agentes inmunodepresores que ocasionan atrofia de órganos linfoides, el mecanismo de atrofia sigue dos vías:

Además de la involución propia de la edad de las aves, son muchos los factores que ocasionan atrofia linfoide.
Las aves, son sometidas durante el proceso productivo a factores de tensión tales como:
Calor.
Frío.
Manejo.
Vacunaciones.
Restricciones de alimento.
Selección y reagrupamiento entre otros.
Los cuales desencadenan la secreción de glucocorticoides que ocasionan apoptosis en células linfoides.
Inhiben la síntesis de proteínas y replicación de los ácidos nucleicos, necesarios para la diferenciación y proliferación de células linfoides y;
Las aves rechazan el alimento, lo cual genera tensión y liberación de glucocorticoides.

Si se aprecia disminución en el tamaño de los órganos linfoides, las micotoxinas deben ser consideradas dentro del diagnóstico diferencial.
En el caso del timo, se presenta atrofia por apoptosis abundante en casos de infección por el virus de la anemia infecciosa. Este virus de transmisión vertical tiene como célula blanco a los linfocitos T y células germinales de médula ósea.

Las aves menores de 5 semanas presentan atrofia severa de corteza de timo, disminuyendo considerablemente el tamaño del timo, en ocasiones durante la necropsia los timos pueden pasar desapercibidos.

Además de la apoptosis, la necrosis también produce atrofia de los órganos linfoides, pero en este caso el proceso inflamatorio puede aumentar el tamaño del órgano de manera transitoria.
En el caso de la bolsa de Fabricio, el agente más conocido es el virus de la infección de la bolsa de Fabricio (IBF), conocida también como enfermedad de Gumboro. Los cambios que el virus ocasiona en la bolsa de Fabricio han sido bien caracterizados.
La necrosis de células linfoides con edema entre los folículos y epitelio germinal, así como la infiltración de heterófilos son los primeros cambios.
Cuando la infección es ocasionada por cepas muy virulentas (cepas calientes) se presentan hemorragias.
Durante los primeros 3 a 5 días la bolsa de Fabricio aumenta de tamaño y después de una semana hay proliferación de células cortico-medulares y fibrosis con disminución de tamaño de la bolsa, el epitelio presenta pliegues y es posible apreciar quistes.
Estos cambios no son exclusivos de IBF, ya que otros agentes como el virus de enfermedad de Marek (EM), Reovirus y virus de la enfermedad de Newcastle (ENC) pueden ocasionar también necrosis e inflamación.
Por esa razón, el diagnóstico de IBF por histopatología debe ir acompañado de la determinación de anticuerpos mediante la técnica de ELISA o virus suero neutralización.

ENFERMEDAD EN CONTINUA

Un caso particular es la infección por virus de IBF por cepas variantes, ya que no ocasionan necrosis e inflamación y la bolsa de Fabricio únicamente se atrofia, estos virus causan la muerte de células linfoides por apoptosis.
En ausencia de infecciones secundarias, la bolsa de Fabricio puede recuperarse después de 8 semanas, en este caso se aprecian zonas de regeneración caracterizadas por una tinción basófila intensa en proximidad de folículos despoblados.
La necrosis e inflamación de timo es rara, generalmente está asociada a la aplicación de vacunas emulsionadas, en este caso se aprecia una reacción granulomatosa.

La regeneración depende de la ausencia de infecciones secundarias, si hay complicación bacteriana o infestación por criptosporidios la bolsa de Fabricio presenta exudado que va desde fibrinoso a fibrinocaseoso que puede llenar la bolsa.
Por otra parte, es posible observar necrosis de células linfoides y hialinización de arteriolas en casos de Enfermedad de Newcastle (ENC) en su presentación velogénica o bien en Influenza Aviar (IA), particularmente con el virus H5N2.
La mayoría de los agentes virales que causan inmunodepresión con necrosis o apoptosis de células linfoides, ocasionan disminución de células en el bazo, y cuando el sistema inmune es estimulado de manera constante por otros virus y bacterias se presenta hiperplasia linfoide.
A simple vista, la superficie de corte se aprecia con puntilleo blanco, que microscópicamente corresponde a nódulos de hiperplasia linfoide. En casos de ENC o IA, se presentan zonas de infarto con hialinización de arteriolas.
En las aves, los virus de Enfermedad de Marek (EM) y Leucosis Linfoide (LL), ocasionan neoplasias de células linfoides (Linfomas) que se presentan en diversos órganos.
Figura 3. Linfoma por enfermedad de Marek en corazón y pulmón de ave de 12 semanas.


La enfermedad de Marek, tiene 5 presentaciones dependiendo el sitio de infiltración de los linfocitos T. Con excepción de la presentación cutánea, el resto de las presentaciones son no productivas transformantes, es decir, no se producen viriones completos y la célula infectada se transforma en neoplásica.
Las manifestaciones clínicas dependen del órgano infiltrado, así las aves presentan:
Ceguera en la presentación ocular.
Parálisis o buche penduloso en la presentación nerviosa.
Diversos trastornos entre los que se incluye diarrea, disnea, insuficiencia renal, ascitis etc.
Lo anterior depende del órgano infiltrado en la presentación visceral. En este caso los órganos presentan nódulos firmes y blancos en la mayoría de los casos. La presentación muscular es la más rara.

Dentro del diagnóstico diferencial con LL, se debe considerar que LL es solamente visceral, por lo que es importante:
El examen de nervios y bolsa de Fabricio.
El aspecto de las células neoplásicas.
La edad de las aves.
La leucosis linfoide presenta infiltración intrafolicular (dentro de los folículos linfoides) en la bolsa de Fabricio y el tumor es frecuente. Mientras que en casos de EM la infiltración en interfolicular (fuera del folículo, ocupando el tejido conectivo entre el epitelio y folículos) y por otra parte la presencia de nódulos es menos frecuente.



La interpretación de lesiones en sistema linfoide, así como las repercusiones en la parvada, requiere una historia clínica detallada, una correcta selección de las aves y es de mucha ayuda las pruebas serológicas complementarias.
Los pollos de desecho o de selección no siempre son lo más representativo de la parvada. Dado que en estas aves los órganos linfoides generalmente presentan atrofia porque su consumo de alimento siempre es menor.
Así mismo, dado que las lesiones en sistema linfoide pueden ser ocasionadas por varios agentes es necesario que el clínico familiarizado con las pruebas serológicas y los resultados que se obtienen.
En los últimos años, las pruebas moleculares han aportado datos valiosos en el diagnóstico y epidemiología de las enfermedades virales inmunodepresoras, sin embargo, no se debe perder de vista que un resultado positivo en una prueba de PCR no siempre tiene valor diagnóstico.
Por ejemplo: en el caso del virus de anemia infecciosa común en pollos de engorde de seis o siete semanas o bien en pollitas de reposición de 10 semanas. A esa edad la infección por el virus no produce inmunodepresión, por lo que la sola presencia del material genético virus en la muestra no necesariamente es el origen del cuadro observado y se deben descartar otras posibilidades.

Patología del sistema inmune en el diagnóstico de inmunodepresión en aves DESCÁRGALO EN PDF
Alfredo Corujo1 y Rosa Franco-Rosselló2
1 Dtor Masterlab (Nutreco Animal Nutrition Iberia)
2 PoultryResearcher (Trouw Nutrition R&D Poultry Research Centre)
Las estrategias recientes en la industria avícola tienen como objetivo reducir tanto la prevalencia como la carga de Salmonella spp. a lo largo de la cadena de producción.


Entre las estrategias de control de Salmonella spp. se incluye la adopción generalizada de vacunas vivas de Salmonella typhimurium en pollos de engorde, que promueven la protección local e inhiben la colonización mediante mecanismos de exclusión competitiva en el tracto gastrointestinal.
Esto ocurre porque las cepas de la vacuna y las cepas salvajes de Salmonella compiten por los mismos sitios de adhesión en el tracto gastrointestinal.

La protección inducida por las vacunas atenuadas de Salmonella depende de una miríada de respuestas inmunitarias, entre las que se encuentran la producción de IgA a nivel local (Carvajal et al., 2008; Dal Bérto et al., 2015).
Como estrategia adicional, que se podría aplicar para potenciar el efecto de las vacunas vivas de salmonella dentro de los programas de control, es la aplicación de inmunoestimuladores, los cuales tienen la capacidad de potenciar la respuesta inmune, aumentando la actividad del sistema inmunitario o algunos de sus componentes.
Dentro de las sustancias


Los niveles de IgA presentes en la mucosa intestinal son uno de los varios parámetros asociados con la protección tras la inmunización frente a Salmonella (Liu et al., 2001; Jawale y Lee, 2014).

vacuna viva frente a IBDV (Virus de la Enfermedad Infecciosa de la Bursa).
En otro trabajo publicado por Barbour et al. (2015), informó de la necesidad de complementar la vacuna frente a Salmonella Enteritidis con una ingesta oral diaria de 250 mg de raíces secas de Echinacea purpurea, desde el primer día de vacunación y hasta 21 días, para obtener una seroconversión estadísticamente significativa.
En un estudio reciente realizado en el Poultry Research Centre de Nutreco, se evaluó la influencia y la respuesta local (producción de IgA) de una formulación a base de extractos de plantas (Inmusal), aplicada en el agua de bebida hasta los 21 días.
ELISA se utilizó el kit AVIPRO Salmonella IgA.
Para cuantificación de IgA fecal, se analizaron 20 pooles por tratamiento y cada pool estaba compuesto de 5 torundas cloacales.
En el primer muestreo (3 días), se obtuvo un 100% de muestras positivas a cepa vacunal, lo que también indicó una correcta aplicación de la vacuna.
Se vacunaron un total de 360 pollos de engorde en incubadora con AviProTM Salmonella VAC T (vacuna viva frente a Salmonella typhimurium, cepa Nal 2/Rif 9/Rt), y la mitad de ellos recibió Inmusal en el agua de bebida
Todos los animales siguieron un programa de alimentación estándar en dos fases, de 0 a 10 días y de 10 a 21 días.
Uno de los objetivos del estudio fue demostrar que la aplicación del producto en agua de bebida a base de extractos de plantas en pollos de engorde vacunados con Salmonella atenuada no afectaba negativamente a la colonización y, en consecuencia, a la excreción de Salmonella vacunada en comparación con el grupo de animales vacunados sin la suplementación del aditivo.


Leyenda 1 Leyenda 2
Figura 1. Nivel de IgA antiflagelina específica tras la vacunación con AviPro™ VAC T. Cada punto del gráfico representa una muestra, la línea vertical se refiere a la desviación estándar, la línea horizontal representa la media y la línea de puntos representa el corte (8,23).

Cabe también mencionar la mortalidad acumulada de 0 a 21 días. Inmusal mostró una tasa de mortalidad más baja (0.56%) durante los primeros 21 días, en comparación con los del grupo control (2.79%) a pesar de no mostrar diferencia alguna en cuanto a los rendimientos productivos.
Con el tiempo se observó una disminución de la excreción de la vacuna de Salmonella.

Podemos concluir, que Inmusal no impactó negativamente la excreción de Salmonella además de mejorar la respuesta inmunológica mejorando la excreción de IgA.
Bibliografía bajo consulta al autor.
Administración de un fitogénico (Inmusal) en agua de bebida como potenciador de la respuesta inmunitaria en pollos de engorde vacunados en incubadora con una vacuna viva atenuada de Salmonella Typhimurium DESCÁRGALO EN PDF






Porque incrementa los niveles y la homogeneidad de títulos IgA y LPS presentes en la mucosa intestinal después de la vacunación, siendo estos los principales parámetros asociados con la protección.
¿Por qué usar InmuSal en pollitos vacunados?
Porque mejora de la capacidad cicatrizante y antiinflamatoria en el intestino, así como el nivel de bacterias acido lácticas, lo cual se traduce en una mayor protección frente a cualquier desafío microbiológico y en una reducción de la mortalidad temprana de los pollitos
Porque incrementa la persistencia de excreción de la vacuna Avipro Salmonella Vac T a los 21 días postvacunación y por tanto la eficiencia de la vacunación.
Objetivo: incrementar el nivel de inmunidad y protección a nivel local del lote de pollos vacunados para minimizar el riesgo de infección por cepas de campo.
Dr. Juan Carlos Rodriguez-Lecompte
Profesor de Inmunología y Enfermedades en la avicultura, en la University of Prince Edward Island
El hígado es un órgano requerido para actividades metabólicas, almacenamiento de nutrientes y procesos de detoxificación.
Clásicamente el hígado es percibido como un órgano no inmunológico, sin embargo, este es inmunológicamente un órgano complejo responsable de la síntesis y producción de proteínas de fase aguda, componentes del complemento, citoquinas y quimioquinas.







Además, aloja una cantidad importante de poblaciones de células inmunes, Figura 1
Remoción de endotoxinas
Detoxificación
Metabolismo de colesterol
Almacenamiento de glicógeno
Producción de albúmina
Figura 1. Rol metabólico e inmunológico del hepatocito.
Bajo condiciones naturales y/o saludables el hígado es continuamente estimulado por una cascada de productos bacterianos con un potencial proinflamatorio significativo, y funciona fisiológicamente como un puente entre moléculas provenientes del intestino y del sistema circulatorio.
Cerca del 80% de la fuente vascular hepática está determinada por el sistema venoso portal que consecuentemente resulta en una baja presión de sangre con cantidades importantes de productos bacterianos y otras moléculas que son presentadas al sistema inmune.
Respuestas de fase aguda
Producción de factores de coagulación
Producción de proteínas antimicrobianas
Presentación de antígenos
Producción de proteínas del complemento
Razonablemente, esas moléculas deben ser toleradas por el sistema inmune, que a su vez es responsable de responder contra amenazas/agresores inminentes, mientras debe mantener en forma constante la inmunovigilancia contra patógenos y enfermedades del hígado.
En un hígado saludable los cambios metabólicos y remodelación de tejidos, más la exposición regular a productos microbianos determinan una inflamación permanente, pero regulada.


Interesantemente, los procesos inflamatorios hepáticos operan en forma rigurosamente controlada y son estimulados a una actividad adicional únicamente cuando el hígado es requerido para deshacerse de patógenos hepatotrópicos, células malignas o productos tóxicos de la actividad metabólica (Hepatotóxicos).
De hecho, la imposibilidad de eliminar estímulos peligrosos y resolver la inflamación, conduce a infección, autoinmunidad o crecimiento tumoral.
Durante una injuria hepática, la consecuente muerte de los hepatocitos causa la liberación de productos celulares muertos (DAMP), lo que activa las células de Kupffer, reclutamiento de neutrófilos en el sitio de la lesión y la activación de células estrelladas hepáticas, lo que lleva a la secreción de citoquinas.
Las células de Kupffer y los neutrófilos liberan mediadores inflamatorios y comienzan a fagocitar los desechos necróticos muertos.
Esto está irremediablemente asociado con inflamación patológica crónica e interrumpida homeostasis tisular, que puede progresar a fibrosis, cirrosis e insuficiencia hepática, Figura 2
HOMEOSTASIS HEPÁTICA
PATOLOGÍA HEPÁTICA
Regeneración del hígado
Tolerancia LPS
Infección aguda
Resolviendo la fibrosis
Figura 2. Inmunología Celular&Molecular (2016) 13, 267-276.
Insuficiencia hepática aguda
Septicemia
Infección crónica
Citosis hepática
HCC


· Eficacia probada por normas UNE oficiales europeas.
· 100% Estable.
· 100% Biodegradable.
El proceso se entiende como rápido y eficaz; durante la resolución, los monocitos adquieren un fenotipo reparador, y los macrófagos se reprograman (fenotipo de resolución).
Los monocitos migran a través de la capa sinusoidal de células endoteliales del hígado, diferenciándose en macrófagos para reponer el conjunto de células de Kupffer o restaurar la homeostasis mediante la secreción de antiinflamatorios citoquinas y promotores de la angiogénesis.
Después de la lesión, surge un fenotipo de macrófagos restauradores, promoviendo neutrófilos y apoptosis.

La proliferación de hepatocitos ocurre para reemplazar el parénquima perdido

Es conocida la increíble capacidad del hígado para enfrentar un sin número de situaciones metabólicas/tóxicas consideradas ‘normales’, que son adversas o nocivas para el animal en función de su tipo, concentración y tiempo de exposición.
Esto conlleva a asumir estructuralmente que para el correcto funcionamiento y mantenimiento de la homeostasis del hígado se hace necesario una protección directa
neutralizando, mitigando y controlando esos eventos inflamatorios, que de perpetuarse
El hígado como órgano nutricional para actividades metabólicas, detoxificación y su acción como órgano linfoide contra patógenos
DESCÁRGALO EN PDF
causarían daños irreparables del hígado como tejido, afectando al rendimiento y la salud general de los animales.









Download the MetAMINO® ATLAS here:
















Estos efectos resultan en un desequilibrio en los sistemas de defensa de las aves, aumentando la susceptibilidad a enfermedades infecciosas o empeorando las condiciones existentes.
Las micotoxinas tienen una gama variada de efectos perjudiciales en las aves, afectando diversos sistemas orgánicos.
Pueden comprometer la función hepática, causar inmunosupresión, interferir en la absorción de nutrientes y provocar trastornos gastrointestinales, lo que puede resultar en:
Disminución del crecimiento,
Baja tasa de conversión alimenticia,
Disminución en la calidad de los huevos
Mayor vulnerabilidad a enfermedades.
La exposición continua a las micotoxinas, enfocándose en la concentración la exposición, también puede afectar considerablemente la productividad, disminuyendo el aumento de peso y la tasa de crecimiento, afectando la eficiencia en la producción de carne y resultando en huevos de menor calidad.
Diferentes tipos de micotoxinas afectan a las aves de distintas maneras:
Las aflatoxinas pueden causar problemas hepáticos, lo que resulta en pérdidas significativas en los índices de rendimiento (Figura 1), inmunosupresión y reducción en la producción de huevos.
Las fumonisinas están relacionadas con trastornos neurológicos en algunas especies, pero en las aves causan importantes pérdidas económicas (Figura 2).
La ocratoxina A tiene efectos negativos en el sistema inmunológico y en la función renal.
Los tricotecenos causan trastornos gastrointestinales, inmunosupresión y reducción en el aumento de peso, además de lesiones especialmente en la cavidad oral.

Por su demostrada eficacia y seguridad, LIDERFEED es el ÚNICO GENUINO PROMOTOR DE CRECIMIENTO español aprobado por EFSA para la UE


(Register of Feed Additives pursuant to Regulation (EC) Nª 1831/2003 – Annex I.List of Additives https://ec.europa.eu/food/sites/food/files/safety/docs/ animal-feed_additives_eu-register_1831-03.pdf) Plaza García Lorca, 15 Bajos Tfno: (+34) 977 552316 43006 Tarragona (Spain) email: lidervet@lidervet.com



































Para minimizar los efectos de las micotoxinas en la producción avícola, pueden implementarse diversas estrategias de control.
Optar por materias primas de alta calidad y evitar ingredientes susceptibles a la contaminación por hongos puede reducir la exposición de las aves a las micotoxinas.
Las medidas preventivas en la pre y post-cosecha también se han desarrollado, como buenas prácticas agrícolas y almacenamiento adecuado para prevenir el crecimiento de hongos productores de micotoxinas.
La utilización de la técnica consagrada de Cromatografía
Líquida de Alta Eficiencia (HPLC) es estándar, pero su limitación es la velocidad de resolución del problema.

Las pruebas regulares para detectar la presencia de micotoxinas en los alimentos ayudan a monitorear y ajustar las formulaciones según sea necesario.
El cálculo del Riesgo de Micotoxinas
Métodos secundarios, como pruebas basadas en kits y espectroscopía de infrarrojo cercano (NIRS), permiten tomar decisiones más rápidas. El NIRS es ventajoso por la velocidad de procesamiento e interpretación por parte de expertos en micotoxinas.

adición de aditivos antimicotoxinas en los alimentos para secuestrar micotoxinas e impedir su absorción en el
con un ambiente controlado y el uso de una nutrición perfectamente controlada para fortalecer el sistema inmunológico de las aves son herramientas que ayudan a mitigar los efectos adversos

Los AAMs tienen diferentes mecanismos de acción, como la adsorción o biotransformación, eliminando eficazmente las micotoxinas a través de las heces, evitando así sus efectos negativos.

La propuesta de utilización de compuestos bioactivos recibe cada vez más atención y su uso ya está confirmado en animales.
La concurrencia de múltiples micotoxinas es una preocupación, resaltando la importancia de los AAMs capaces de neutralizar una amplia gama de ellas.
Sin embargo, la elección del mejor AAM no es única para todas las micotoxinas. Antes de seleccionar un producto, es crucial definir qué toxinas se desean controlar,conociendo sus características moleculares e interacciones con los productos
Otros métodos de control químico incluyen inactivadores químicos, agentes oxidantes y agentes alquilantes, pero pueden tener efectos colaterales perjudiciales y aún deben desarrollarse en el futuro con nuevos enfoques.
Las micotoxinas impactan significativamente en la productividad y salud de las aves, con implicaciones directas en la industria y seguridad alimentaria. Implementar estrategias de control efectivas es crucial para reducir los riesgos de contaminación.

La investigación continúa y los conocimientos son esenciales para desarrollar enfoques y tecnologías que minimicen los efectos perjudiciales.
Al adoptar medidas preventivas y correctivas, la industria avícola puede garantizar una producción más sostenible, beneficiando a los animales, la economía y los consumidores.


PROTECTING THE PLANET FOR FUTURE GENERATIONS
Para la industria del pollo durante los últimos 20 años
EFICIENCIA MEJORADA
El pollo moderno es más eficiente biológicamente por kg de peso vivo: 40 EXTRA DE RENDIMIENTO CÁRNICO gr.
320 gr.
MENOS DE ALIMENTO USO DEL AGUA
MENOS 0.57L
Requerido por 1,0 kg de pollo
Y además se incrementan la viabilidad, la salud y el bienestar animal a través de la selección balanceada
MEJOR INGESTA DE AGUA =
Mejor Salud Intestinal
Mejor calidad de la yacija
Mejor salud plantar
Más uso del agua eficiente y sostenible
Mejora en Índice de Conversión y periodos de crías más cortos = POTENCIAL DE CALENTAMIENTO GLOBAL REDUCIDO
19 %
DE EMISIONES DE GASES DE EFECTO INVERNADERO
REDUCCIÓN DEL POTENCIAL DE CALENTAMIENTO GLOBAL
Mejor IC = Mejor utilización de los nutrientes 28%
MENOR EXCRECIÓN DE NITRATO Y FOSFATO
Progreso de peso vivo, periodos de cría más cortos y menor producción de alimento y transporte=
MENOR USO DE LA TIERRA & MENOS TRANSPORTE
Mejora del I.C. = un pollo de 2,5 kg consume… 0.8 kg
DE ALIMENTO MENOS
MENOS ALIMENTOS SUPONE…
MENOS DE TIERRAS AGRÍCOLAS
requeridas para la producción de alimentos para la cría de pollo 42%
Descubre más sobre cómo Aviagen® protege el planeta para
19 %
MENOS DE CONSUMO DE ENERGÍA
18.3% DE REDUCCIÓN
MENOS VIAJES
Para suministrar materias primas y alimento para pollos